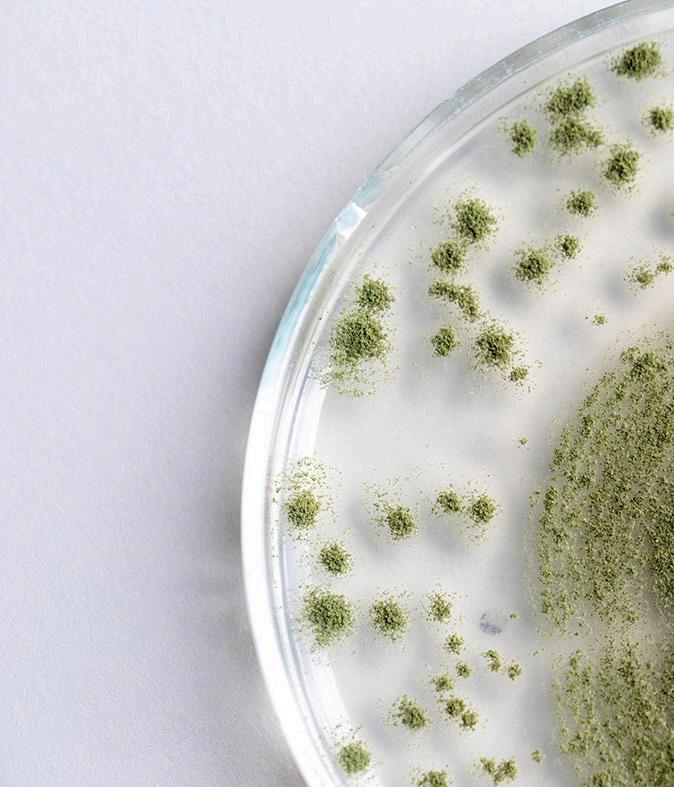

Don't waSte energy!!!


Complementary feed rich in emulsifiers and polyphenols from vegetal origin.
Visible savings and A step towards sustainable nutrition.


![]()





Don't waSte energy!!!


Complementary feed rich in emulsifiers and polyphenols from vegetal origin.
Visible savings and A step towards sustainable nutrition.


Livestock health is vital to the global food supply, as animals provide essential products like meat and dairy. However, the sector faces a significant threat from mycotoxins dangerous toxins produced by fungi that can contaminate feed. These toxins compromise animal health, productivity, and, ultimately, food safety. The use of antimycotoxins in feed has become a crucial strategy in mitigating these risks, but it requires careful consideration.
Mycotoxins, such as aflatoxins, ochratoxins, and fumonisins, frequently contaminate cereals, grains, and other feed ingredients. They are resilient and thrive under various conditions, making contamination a persistent issue. When livestock consume contaminated feed, it can result in immune suppression, stunted growth, reproductive problems, and even death. Moreover, these toxins can end up in animal products, posing health risks to humans and underscoring the need for effective control measures.
To combat mycotoxin contamination, antimycotoxins—substances like binders, detoxifiers, and biological agents—are added to feed. These agents work by binding to toxins, breaking them down into non-toxic forms, or preventing their absorption in the digestive tract. Incorporating antimycotoxins into feed helps protect animal health and ensures the safety of animal-derived products.
Binders, such as clay minerals or organic polymers, adsorb mycotoxins in the digestive system, preventing their entry into the bloodstream. Detoxifiers, including enzymes and microorganisms, degrade mycotoxins into less harmful compounds. These targeted approaches are highly effective in managing specific mycotoxins.
Despite their promise, the use of antimycotoxins is not without challenges. Effectiveness can vary depending on factors like the type of mycotoxin, feed composition, and the animal’s digestive conditions. Additionally, the cost of antimycotoxins can be prohibitive for farmers in developing regions with limited resources.
Regulatory challenges also exist. Antimycotoxins are subject to strict regulations designed to ensure safety and efficacy, but these regulations can complicate compliance for farmers and feed manufacturers. Furthermore, the ever-evolving threat of mycotoxins due to new fungal strains and changing environmental conditions necessitates ongoing research and innovation in antimycotoxin technology.
A multifaceted approach is essential for maximizing the benefits of antimycotoxins. Farmers and feed manufacturers should implement comprehensive mycotoxin management strategies, including rigorous quality control measures like regular testing of feed ingredients and finished products, as well as proper storage practices to reduce fungal contamination.
Education and awareness are also key. Farmers must be equipped with the knowledge to manage mycotoxin risks effectively, recognizing signs of exposure in livestock and responding quickly.
In conclusion, antimycotoxins are a critical component of livestock health management. Despite the challenges, the benefits of using these agents in feed far outweigh the risks. By adopting a proactive approach, the agricultural sector can protect livestock health, ensure food safety, and sustain farming practices against the ongoing threat of mycotoxins. With the right tools and strategies, the fight against mycotoxins is a battle that can be won.
EDITOR COMMUNICATION GROUP AGRINEWS LLC
ADVERTISING
Luis Carrasco +34 605 09 05 13 lc@agrinews.es
Simone Dias +55 11 9 8585-2436 nutribr@grupoagrinews.com
CUSTOMER SUPPORT
Mercé Soler
EDITORIAL STAFF
Álvaro José Guzman Viviana Schroeder
TECHNICAL DIRECTION Dr. Edgar Oviedo (poultry)
info@grupoagrinews.com nutrinews.com grupoagrinews.com
Free distribution magazine AIMED AT VETERINARIANS AND TECHNICIANS Legal Deposit Nutrinews B11597-2013
Subscription price 125$
Legal Deposit: B15281-2024 ISSN 2938-8929
Images: Noun Project / Freepik/Dreamstime



Methionine in Poultry Diets and Its Role in Antioxidant Prevention in the Body - Part I

Tainara CIuffi E. Dornelas
Doctor in Animal Production
Technichal Coordinator of nutriNews Brasil
with Eimeria spp.



Cinta Sol1 , Gerardo Villalobos1 , Felipe Horta1 , Jihwan Lee 2 and Woo Kyun Kim2
1Nuproxa Switzerland Ltd.
2Department of Poultry Science, University of Georgia, USA
Preview of the 10th Revised Edition of The Nutrient Requirements of Poultry (2024)

Edgar O. Oviedo Rondón
Prestage Department of Poultry Science, North Carolina State University. Raleigh, NC
Dr. Susanne Rothstein & Sarah Gravemeyer

Keys to feeding piglets without zinc oxide

Gonzalo Gonzalez-Mateos Professor of Swine Medicine and Reproduction, Farm Animals Clinic, School of Veterinary Medicine, Aristotle University of Thessaloniki, Greece
| CELMANAX supplementation in sow and nursery pig diets improved sow and finishing pig performance in commercial research trial
S. Jalukar1 , C. Rippe, and S. Fribourg2
1 Arm & Hammer Animal Nutrition, Princeton, NJ
2 Adisens, Peru

Carolina Kyriacou
1Dairy Consultant at Vettaky Ltd, University of Wageningen, Netherlands
Risk factors in hoof health in dairy cows
Fernando Ignacio Castillo Ortega Veterinarian Zootechnician from the Autonomous Agrarian University Antonio Narro (UAAAN) - Laguna Unit, Saltillo, Coahuila, Mexico
Definition & classification

Palm kernel cake and palm kernel meal are derived as by-products from the extraction of oil from the seeds of the African oil palm (Elaeis guineensis), a species predominantly cultivated in tropical regions of Africa and Asia.





Almost 80% of the world’s palm oil production originates from Indonesia and Malaysia. Other producing countries are: Nigeria, Thailand, Colombia, Papua New Guinea and Ecuador (FAO, 2012). However, the production of the aforementioned countries is significantly lower compared to the major producers. Europe and New Zealand are major importers of palm kernel meal and cake. In Malaysia and Indonesia, palm oil production takes place in large areas which are generally run by private companies. However, in other regions, such as in West African countries, its production is divided among small farmers.

Palm oil production is generally associated with deforestation and loss of biodiversity. This is especially true in Southeast Asia, due to the type of production system used in this region. These factors have faced significant scrutiny from the public, particularly in Europe, which stands as the primary importer of these raw materials.



In 2008, the Roundtable on Sustainable Palm Oil (RSPO) developed a voluntary certification system to ensure sustainable production.

Recent research suggests that obtaining this certification leads to a 35% reduction in greenhouse gas emissions when compared to productions that are not certified. (Schmidt & De Rosa, 2020). Thus, reducing the environmental impacts of this industry.
The “Catalogue of raw materials” (Regulation (EU) 68/2013) classifies palm kernel cake and meal for animal feed, in the following section: “2. Oil seeds, oleaginous fruits and their derived products” (Table 1).
It is mandatory to declare the protein and fiber content in the cake, as well as its fat content.
Table 1. Classification of palm kernel according to the Catalogue of Raw Materials (Regulation (EU) 68/2013).
Number Denomination
2.12.1 Palm kernel expeller
2.12.2 Palm kernel meal
Description
Product of oil manufacture, obtained by the pressing of palm kernels Elaeis guineensis Jacq.,Corozo oleifera (HBK) L. H. Bailey (Elaeis melanococca auct.) from which as much as possible of the hard shell has been removed.
Product of oil manufacture, obtained by extraction of palm kernels from which as much as possible of the hard shell has been removed.
Compulsory declarations
Crude Protein Crude Fiber Crude Fat
Crude Protein Crude Fiber
The oil palm fruit has: a fine epicarp, a fleshy, oily mesocarp and a hard endocarp containing an endosperm (kernel, seed). Palm oil is extracted from the mesocarp and it is rich in long-chain fatty acids such as palmitic and oleic acids.


In a second phase, the seed is fragmented in order to release the endosperm. Seeds are then usually derived to other processing units where they are subjected to pressure or solvent treatments to extract palm kernel oil, which is rich in medium-chain fatty acids (lauric, myristic).
The three basic steps followed in the mechanical extraction of palm kernel oil are: steam pretreatment of the seed, pressing of the seed, rinsing and filtering of the oil (Figure 1, Poku, 2002).
After this mechanical extraction, some of the specialized processing plants apply solvent degreasing agents.
The cakes and meals derived from this process are intended for animal feed.
The remaining (57%) is palm kernel cake, which usually contains 35% pericarp and 65% fruit. Seed cleaning

According to Pickard (2005), the yield of oil extraction from the nuts (seeds) of the oil palm is approximately 43%.

Palm kernel cake and meal are by-products of oilseeds. However, these have significantly lower energy and protein values than other better-known oilseed derivatives such as: soybean, rapeseed or sunflower meal /cake.
This stems from the fact that it has a reduced protein ratio (17-19%) and a significant amount of fiber (60-70% NDF), which is notably lignified.



Its high content of galactomannans is noteworthy, which imparts a certain insolubility to the fiber. The fiber comes from the seed coat, and its content is variable, resulting in a high variability in its nutritional value.
As with other raw materials:
Cakes (oil extraction through pressure) contain a higher fat content (8-9%),
than meals (solvent oil extraction, 2-3%). Therefore, cakes can provide a higher energy value for animals.
Unlike what happens with other oilseeds, the cake is more commonly used in animal feeding than the meal.
Table 2 includes the composition provided by FEDNA for soybean, rapeseed, and palm oils, as well as soybean oleins and palm distillates. This table also contains the composition published by INRAE-C RAD-AFZ.
Except for FEDNA tables, other common feed tables such as those from INRAE or CVB do not provide the composition of industrial by-products derived from fats.
Table 2. Chemical composition (on a dry matter basis) of palm kernel cake and meal


Natural feed sweetener based on steviol glycosides, extracted from the plant Stevia rebaudiana
THERMOSTABLE UP TO 198 OC
HIGHLY WATER SOLUBLE
STABLE OVER A WIDE PH RANGE NOT METABOLISED IT DOES NOT FERMENT
It provides a more intense, stimulating, homogeneous and persistent sweetness.
It triggers a hedonic effect that increases feed intake, stimulates digestive secretions, promotes nutrient absorption and improves zootechnical indices.
Standardised product with rigorous controls on all batches.
Authorised in the European Union with no legal limits on dosage, animal species or age, according to EFSA.
Available in both liquid and solid versions.
APSABOR REPRESENTS AN EFFECTIVE AND NATURAL SOLUTION TO IMPROVE FEED PALATABILITY, INCREASE FEED INTAKE AND OPTIMISE ANIMAL PRODUCTIVITY www.linneos.com
1 https://www.feedipedia.org/node/707; values expressed on a dry matter basis.
2 http://www.fundacionfedna.org/ingrediente; values expressed on a dry matter basis.
3 https://feedtables.com/content/table-dry-matter; values expressed on a dry matter basis.
4 Polarimetry analysis.
The percentage of various amino acids (AA) is low compared to other oilseed by-products (Figure 2). However, the profile is similar to that of the protein in sunflower and rapeseed cakes and meals.
The content of fatty acids is naturally higher in the cake compared to the meal, and its notable content of lauric and myristic acids stands out, which are characteristic of palm seeds, along with its high oleic acid content.

0,50
0,00
Within rabbit nutrition, these by-products prove to be valuable sources of both fiber and protein, effectively fulfilling the nutritional needs of highly productive rabbits. (de Blas et al., 2010). 3,30 3,00 2,50 2,00 2,50 2,00
Sunflower cake pressing 31%CP
Rapeseed meal 00 Solvents 33%PB
Soybean meal 44
Palm kernel cake exhibits various antinutritional factors , such as 0.40% tannic acid, 6.62 mg/g phytic acid, 23.49 mg/g phytic acid, and 5.13 mg/g oxalate, which have adverse effects on the nutritional quality of palm kernel cake (Akinyeye et al., 2011).

Palm by-products have traditionally been used in ruminant feed due to their high fiber content. Among these, palm kernel cake and meal are protein ingredients with low degradability for both energy and protein. Furthermore, their fat content is relatively inert to rumen microorganisms.
kernel meal solvents
meal 28
cake 00 pressing 12.7EE
In regions with high productivity like Malaysia, dairy cow diets can incorporate as much as 50% palm kernel cake, while reducing the use of soybean and corn, all without adversely affecting animal production and health.
In dairy breeds, inclusion levels of 15% have been deemed safe to maintain animal production and health levels. Moreover, there's even an indication that it might lead to a rise in protein concentration in milk (Carvalho et al., 2006).
In other monogastric species such as pigs and poultry, these ingredients have a low nutritional value. This is mainly due to their their high fiber levels, as well as due to their low palatability.
The recommended levels of inclusion are approximately 5-10% for poultry and 15-25% for pigs (Wan Zahari et al., 2005; Zanu et al., 2012, respectivamente), although these proportions can vary based on the quality of the cakes and meals employed.
Furthermore, recent studies suggest that the solid-state fermentation treatment of these raw materials decreases their fiber content by breaking down the more complex carbohydrate fractions. This enhances their nutritional value and enables higher inclusion levels in broilers (10-15%; Azizi et al., 2021).
Other treatments such as hydrolysis with mannanases or the inclusion of mannanases in feeds seem promising to enhance the nutritional value of these ingredients in monogastric nutrition (Jang et al., 2020; Sathitkowitchai et al., 2022).
It's also important to consider that these ingredients contain bioactive lipids, such as lauric acid, which can have antimicrobial effects and are also a potential source of prebiotics. This can positively impact animal health.

Palm kernel cake and meal are fibrous ingredients with good acceptance levels in ruminant production. These can also be used in pig feeding but with certain limitations.
Efforts aimed at enhancing the sustainability of palm oil production and elevating the nutritional worth of these by-products stand as pivotal factors in augmenting the utilization of these raw materials in animal feed.

Bibliographical references available in the online version of the article.


Updated Table 2024



COUNTRIES OF DISTRIBUTION
ADDITIONAL INFORMATION
SPECIFIC EFFECTIVENESS ON THE TYPE OF MYCOTOXIN(S)
DOSE
COMPOSITION
United States, Mexico, Guatemala, El Salvador, Honduras, Costa Rica, Panama, Dominican Republic, Nicaragua, Colombia, Ecuador, Venezuela, Peru, Chile, Argentina, Brazil, Uruguay, Paraguay, Spain, South Korea, Japan, Philippines, India, China, Malaysia
Formula ready to use for feed mills and farmers. Please note that due to different registration requirements, the ingredient description is slighty different in different countires. Check with regional representatives to confirm.
Broad-spectrum efficacy against multiple mycotoxins: Aflatoxin, Fumonisin, Ochratoxin, DON, T2 and Zearalenone
Dairy: Lactating cows: 28g/hd/day Beef: Feedlot and cows: 10-15 g/hd/day
Poultry: 1kg/ton
Swine: Sow: 2 kg/ton Nursery: 2 kg/ton Grow/Finish: 1 kg/ton
Preparation of biologically active RFCs™ (Refined Functional Carbohydrates™) and Bentonite
BG-MAX™ Midds or BG-MAX™
COUNTRIES OF DISTRIBUTION
ADDITIONAL INFORMATION
Broad spectrum mycotoxin binder
SPECIFIC EFFECTIVENESS ON THE TYPE OF MYCOTOXIN(S)
DOSE
B.I.O.Tox Bentonite, yeast products, vegetal carbon and sepiolite
COMPOSITION

*Proven efficacy in “ in vivo ” and “ in vitro ” experiments.
*Triple action antimycotoxicant: physical trapping mechanism, polar attraction mechanism, inhibition and destruction. Worldwide
Wide spectrum of mycotoxin adsorption: Aflatoxins, Ochratoxin, T-2, Vomitoxin DON, Zearalenone
Mixture of activated aluminosilicates with surfactants and mycotoxin destroying agents. From 1 to 3 kg/tonne of feed, depending on the level of mycotoxin contamination
®
Primus
Toxidex
Contact our sales team for the specific product according to your location and your nearest distributor at: info@liptosa.com
Selected clays
Broad spectrum activity against mycotoxins and other endotoxins.
Fructooligosaccharides Botanicals Betaine Natural antioxidants 1-2 Kg/t of feed depending on the degree of contamination AFB1, AFB2, AFG1, AFG2, AFM1, ZEA, T-2, OTA, FB1, DON, Citrinina, Fumitoxina
Yeasts and their parts
® PRODUCT
FINTOX
RANGE



COUNTRIES OF DISTRIBUTION
ADDITIONAL INFORMATION
DOSE SPECIFIC EFFECTIVENESS ON THE TYPE OF MYCOTOXIN(S)
COMPOSITION

Highly effective mycotoxin binder that adsorbs the most dangerous mycotoxins. It operates independently of pH levels, and provides fast action against mycotoxins after feed intake. It selectively preserves essential nutrients such as vitamins and amino acids, and is exempted from toxic compounds (e.g. dioxins and PCBs).
Aflatoxin B1 (AFB1) / Zearalenone (ZEN) / T-2 toxin / Fumonisin B1 (FB1 ) / Ochratoxin A (OTA) / Ergot alkaloids toxins (EAs).
® Bentonites (1m558; 1m558i) / Sepiolitic clay. From 0.5 to 3.0 kg/t of feed, depending on the level of mycotoxins contamination.
® QUIMITŌX
BIŌNTE
Africa, Asia, Europe, LATAM and Middle East.
Evaluated efficacy based on toxicokinetic studies and biomarkers of exposure to mycotoxins on different target species, under EFSA regulations.
Anti-mycotoxin solution with triple action: adsorption / bioprotection / post-biotic effect. Effective against: Aflatoxins (AFB1, AFB2, AFG1 and AFG2), Fumonisins (FB1, FB2 and FB3), Zearalenone (ZEN), T-2 and HT-2 toxins , Ochratoxin A (OTA), Deoxynivalenol (DON; by detoxification), Ergot alkaloids toxins (EAs), Emerging mycotoxins (Beauvericin: BEA; Enniatins: ENN A, ENN A1, ENN B and ENN B1; Stregmatocystin, STC), Modified mycotoxins (Zearalenone Glucuronide; ZEN 14-G).
® PLUS Bentonites (1m558; 1m558i) / Sepiolitic clay / Mixture of phytogenics extracts (Turmeric and Milk thistle extracts) / Yeast cell wall and hydrolyzed yeast. From 1.0 to 3.0 kg/t of feed, depending on the level of mycotoxins contamination.
® QUIMITŌX
BIŌNTE
A metabolic multi-action complex that mitigates the collateral effects of mycotoxins such as intestinal integrity impairment, oxidative stress and target organs alterations: The administration on continuous basis, boosts the productive parameters and enhances animal products quality (meat, egg, milk).
A systemic health solution that increases cell viability, shows antimicrobial activity against Salmonella entérica, Shigella dysenteriae, Staphylococcus aureus and Yersinia enterocolitica ; improves water quality and reduces the bioavailability of emerging mycotoxins in liver (Tenzuanoic acid).
From 1.0 to 2.0 mL/L of drinking water.
® Liquid solution based on a mixture of phytogenics extracts (Grape and olive extracts) / Essential minerals / Emulsifiers / Preservatives.
BIŌNTE ® QUIMITŌX ® LIVŌX
Mycotoxins binder for aquatic species that offers a complete solution to face the mycotoxicoses challenge of aquaculture.
Aflatoxin b1 (AFB1) / Ochratoxin A (OTA)/ Zearalenone (ZEN) / T-2 toxin / Fumonisin B1 (FB1).
From 1.0 to 3.0 kg/t of feed, depending on the level of mycotoxins contamination.
Selected bentonite (1m558i) / Sepiolitic clay / Phytogenic feed additive (Orange peel meal).
BIŌNTE ® QUIMITŌX ® AQUA
Anti-mycotoxin solution for highly sensitive aquatic species to mycotoxins and phycotoxins with a triple mode of action: adsorption, bioprotection and post-biotic effect.
Aflatoxins / Fumonisins / T-2 and HT-2 toxins / Deoxynivalenol (DON) / Emerging mycotoxins (Beauvericin, Enniatins, Stregmatocystin) / Modified mycotoxins.
From 1.0 to 3.0 kg/t of feed, depending on the level of mycotoxins contamination.
Selected bentonite (1m558i) / Sepiolitic clay / Mixture of phytogenics extracts (Turmeric and Milk thistle extracts) and emulsifier / Yeast cell wall and hydrolyzed yeast.
BIŌNTE ® QUIMITŌX ® AQUA PLUS



Worldwide
The combination of the Myco-Marker TM service and Escent® technology make up the RISE® platform. The Myco-Marker TM service allows tofor the first timemeasure the real impact of mycotoxins on health and productivity and to optimize the mitigation strategy with the detoxifier (Escent®). Escent® has multiple modes of action, all of which have been shown in vivo to help animals combat stress: * Support the liver and kidneys * Prevent oxidative stress * Elevate the immune response * Increase detoxification * Adsorb (myco)toxins.
Excellent efficacy demonstrated in vivo for all major mycotoxins: * Deoxynivalenol * Aflatoxins * Fumonisins * Zearalenone * T-2 * Ochratoxin A * Ergot * Emerging mycotoxins
Poultry and pig: 0.53 kg/T Ruminants: 20-40 g/ animal/day
® * Mixture of clays * Yeast * Antioxidants * Hepatic and renal protectors
ESCENT
Myco-Marker™, an industry first blood biomonitoring tool, transforms cutting-edge science into practical applications, offering superior diagnostics and informed decisionmaking. Blood is collected using FTA cards to facilitate the sampling process on farms, requiring just one drop of blood per animal.
Myco-Marker TM The real mycotoxin biomonitoring reference. The threat to 36 mycotoxins revealed with just 1 drop of blood
Mexico
The adsorbent production plant operates under the HACCP food safety system and holds ISO 22000 accreditation and FAMI QS certification. Additionally, it is equipped with laboratories capable of conducting both in vivo and in vitro tests, accredited according to the Mexican Official Standard 17025 for testing and calibration laboratories. The plant also has accredited methods with the Mexican Accreditation Entity (EMA) and holds Good Manufacturing Practices (GMP) certificates issued by SADER. All products are evaluated by the reference laboratory Trilogy Analytical Labs, with satisfactory results. The products are free from dioxins (as verified by Eurofins Analytics France [Nantes]), heavy metals, and other microbiological contaminants. The latter is assessed through the aerobic plate count method, as established in NOM-092-SSA1-1994.
COMPOSITION DOSE SPECIFIC EFFECTIVENESS ON THE TYPE OF MYCOTOXIN(S)

Preventive dosage: 0.751.0 kg/ton
Clinical cases dosage: 1.5 kg/ton
Chemically activated calcium and sodium aluminosilicate with an organic compound (Organoaluminosilicate)
Aflatoxins, Fumonisin B1, Ochratoxin A, T2 Toxin, Zearalenone
Preventive dosage: 1.02.0 kg/ton
Clinical cases dosage: 3.0 kg/ton
Partially activated calcium and sodium aluminosilicate with an organic compound (Organoaluminosilicate)
Zeotek ®
Duotek ®
Aflatoxins & Fumonisin B1
Preventive dosage: 2.5 kg/ton
Clinical cases dosage: 5.0 kg/ton
Liquid solution based on a mixture of phytogenics extracts (Grape and olive extracts) / Essential minerals / Emulsifiers / Preservatives.
Zeolex ® Extra


COUNTRIES OF DISTRIBUTION

Worldwide Further question: toxininactivation@miavit.de
ADDITIONAL INFORMATION
• Toxin-inactivation = Adsoprtion (AFL, OCT, ZEN, Ergots)
+ highest binding capacity of endotoxins
• Toxin-inactivation = Adsoprtion (AFL, OCT, ZEN, Ergots)
+ highest binding capacity of endotoxins
• Advanced cell protection = Mixture of polyphenolic compounds
• Toxin-inactivation = Adsorption (AFL; OCT; ZEN; ERGOT)
+ Biotransformation (DON)
+ Biodegradation (FUM)
• Cell protection = Mixture of flavouring compounds
• GIT balance = Combination of toxin inactivation and natural ingredient
COMPOSITION DOSE SPECIFIC EFFECTIVENESS ON THE TYPE OF MYCOTOXIN(S)
Aflatoxin Zearalenon Ergotalkaloids Ochratoxin A Bacterial endotoxins
Monogastric: 0.5 –3 kg/t of finished feed
Ruminants: 30120 gr / head/ day
• Bentonite (1m558)
Aflatoxin Zearalenon Ergotalkaloids Ochratoxin A Bacterial endotoxins
Monogastric: 0.5 –3 kg/t of finished feed
• Bentonite (1m558)
Ruminants: 30120 gr / head/ day
• Mixture of phenolic compounds
MiaBond
MiaBond BP
Aflatoxin Zearalenon Ergotalkaloids Ochratoxin A Fumonisin B1 and B2 All Trichothecene (DON, DAS etc) Bacterial endotoxins
Monogastric: 1 –3 kg per ton of finished feed Ruminants: 30120 gr / head/ day
• Bentonite (1m558) Anaerobic bacteria to biotransform trichothecenes (eg. DON)
MiaBond 360
• Esterase enzyme to biodegrade FUM
• Mixture of flavouring and natural ingredients
• Toxin-inactivation = Biodegradation (FUM)
• GIT booster = Synbiotics effects of probiotics and prebiotic + toxin-inactivation
• Immune modulator = mixture of natural ingredients
Pigs and poultry: 100-200 gr/ 1000 l of drinking water Fumonisin B1 Fumonisin B2
• Esterase enzyme to biodegrade FUM
• Mixture of natural ingredients
MiaBond Drink
• Mixture of probiotics and prebiotic Energy sources
• Toxin-attachment = Bentonite and clinoptilolite
• Supporting ammonia reduction = clinoptilolite
• Immune modulator and cell protection = organic trace element, mixture of flavouring and prebiotic compounds
Aflatoxin Zearalenon Ergotalkaloids Ochratoxin A Bacterial endotoxins
Fish and shrimp: 0.5 –3 kg per ton of finished feed
• Mixture of flavouring compounds Organic trace element Prebiotic compound
Aqua Bentonite and clinoptilolite
MiaBond
Viviana Schroeder
Marketing Executive in the feed additives industry

Years pass by and mycotoxin control keeps being critical in animal feeding. Antimycotoxin research and product development are ongoing topics in the animal feed industry.

ANIMAL HEALTH AND PERFORMANCE:
Mycotoxins, such as Aflatoxins, Fumonisins, and Deoxynivalenol (DON), can cause a wide range of health issues, including immune suppression, liver and kidney damage, reduced feed intake, and impaired growth. Chronic exposure leads to long-term health issues, lower productivity, and higher susceptibility to diseases.
ECONOMIC LOSSES:
Mycotoxins result in significant financial losses for farmers due to reduced animal productivity, increased veterinary costs, and the need for expensive detoxification strategies. Contaminated feed may also need to be discarded or treated, adding to the costs.
Mycotoxins can enter the food chain through animal products such as milk, meat, and eggs. Aflatoxin B1, for example, can be converted into Aflatoxin M1 in dairy cows and contaminate milk. Strict regulations are in place to limit mycotoxin levels in both animal feed and food for human consumption to prevent health risks.
Many countries have stringent regulations on allowable levels of mycotoxins in feed and food.
Exceeding these limits can result in product recalls, legal penalties, and loss of market access, particularly for exportoriented industries.
IMPACT ON REPRODUCTIVE PERFORMANCE:
Mycotoxins like Zearalenone mimic estrogen, causing reproductive issues in livestock, especially pigs.
This can lead to reduced fertility, miscarriages, and poor offspring development, further impacting farm profitability.
Thus, effective mycotoxin management ensures healthier animals, better production efficiency, and safer food products.
Today we know that controlling mycotoxins in animal feed requires a multifaceted approach due to the complex nature of contamination. It cannot be achieved by separated actions. The key factors in mycotoxin control are:
1

PREVENTION AT THE SOURCE:
Effective mycotoxin control starts with managing raw materials. This involves using good agricultural practices (GAP) such as crop rotation, controlling humidity and temperature during harvest and storage, and reducing insect damage that promotes mold growth.
Monitoring and ensuring feed is stored in dry, well-ventilated environments can prevent mold proliferation.
3
USE OF MYCOTOXIN BINDERS:
Adsorbents such as bentonite, zeolite, and activated carbon can bind mycotoxins in the gastrointestinal tract of animals, preventing absorption into the bloodstream. More advanced binders target specific mycotoxins, ensuring broader protection against contamination.
2
REGULAR TESTING AND MONITORING:
Frequent testing of feed ingredients and finished products for mycotoxin contamination is essential. Rapid testing methods like ELISA and LC-MS/MS are widely used to detect mycotoxins like Aflatoxins, Fumonisins, and Zearalenone.
Early detection allows for prompt intervention and prevents contaminated feed from reaching animals.
4
DETOXIFICATION AGENTS:
Enzyme-based solutions and biological detoxifiers are increasingly used to degrade mycotoxins into less harmful compounds.
Enzymes can break down specific mycotoxins such as fumonisins, while probiotic strains like Lactobacillus can reduce mycotoxin impact by modifying their bioavailability.
5
6
ANIMAL HEALTH MONITORING AND BIOMARKERS:
Monitoring animal health using biomarkers is an emerging strategy for controlling mycotoxins. Blood-based biomarker testing can detect the biological impact of mycotoxins in animals, helping farmers intervene early and adjust feed management practices.
COMPREHENSIVE FEED MANAGEMENT:

Combining the use of binders, regular feed testing, proper storage, and detoxifying additives in an integrated mycotoxin control program can help minimize risks.
This holistic approach ensures that all aspects of feed production and storage are optimized to reduce contamination. Together, these strategies ensure effective control over mycotoxins, improving animal health, feed safety, and farm profitability.
What has been done in the industry to mitigate mycotoxin negative effects?
Recent developments in anti-mycotoxin trends for animal feed focus on enhancing the effectiveness of mycotoxin control and detoxification strategies. A key trend is the use of innovative mycotoxin binders and biotransformation agents.
These products are designed to deactivate a broad spectrum of mycotoxins like Aflatoxins, Trichothecenes, and Zearalenone.
Additionally, natural binders like clay and activated minerals, are becoming more prevalent due to their ability to absorb toxins without impacting nutrient absorption.
Other trends include using yeast cell walls, enzymes, and probiotics that not only bind toxins but also improve gut health and immune response.

These products help mitigate oxidative stress and enhance overall animal performance, especially in environments with high toxin exposure.




Which are the actual methods used to evaluate mycotoxins in feed stuff?
New methods for evaluating mycotoxin presence in animal feed are advancing rapidly, driven by the need for more sensitive, faster, and cost-effective testing. Here are some of the key innovations:
This technique is becoming widely popular due to its low cost, simplicity, and rapid results. It uses antibodies to detect mycotoxins in feed samples and is now being enhanced with new fluorescent materials such as quantum dots and carbon-based nanoparticles, increasing sensitivity and accuracy.
LFIA can now detect multiple mycotoxins simultaneously using different signal labels, making it more efficient for real-time monitoring.
This method remains a gold standard for its high sensitivity, especially for complex feed matrices. It can detect low levels of mycotoxins and identify multiple mycotoxins in one run, but it is more expensive and requires advanced laboratory equipment.
Despite these drawbacks, it is particularly useful in research and feed mills that need precise quantification.
Recent developments in biosensors, particularly those utilizing nanomaterials like gold nanoparticles, have improved the detection of mycotoxins at lower levels.
These sensors are often paired with technologies like fluorescence and electrochemical detection, enabling fast and precise analysis of contaminated samples.
High-throughput screening methods are now available for testing large volumes of samples quickly, particularly beneficial in commercial feed mills.
These systems integrate multiple detection technologies, offering a balance between sensitivity and speed, essential for regular monitoring and compliance.
These methods allow for earlier and more accurate detection of mycotoxins in feed, enabling better prevention and control strategies in animal production systems. As technology evolves, there is an increasing emphasis on portable, user-friendly devices suitable for on-site testing, reducing reliance on laboratory analysis.
Research highlights the importance of comprehensive mycotoxin management programs, including advancements in testing technology and multi-mycotoxin analysis, to address contamination in alternative feed commodities.
Recent research in anti-mycotoxin strategies for animal feed has introduced innovative solutions aimed at improving mycotoxin detoxification, enhancing animal health, and ensuring feed safety.
Key advancements include:

ENHANCED MYCOTOXIN BINDERS AND ADSORBENTS:
Traditional binders like bentonites and activated clays are evolving. New formulations target a wider spectrum of mycotoxins, including Aflatoxins, Zearalenone, and Deoxynivalenol (DON).
Nanomaterials, including nanoclays and engineered zeolites, are being studied for their enhanced ability to trap toxins without affecting nutrient absorption.

There’s growing interest in biological detoxifiers, such as specific enzymes, microorganisms, and yeast-based products, which can metabolize mycotoxins into non-toxic byproducts.

For instance, Trichosporon mycotoxinivorans, a yeast species, has shown promise in degrading certain mycotoxins like ochratoxin A.
PROBIOTICS AND GUT HEALTH:
Probiotic strains such as Lactobacillus and Saccharomyces have been found to not only improve gut health but also assist in mitigating the effects of mycotoxins by binding or transforming them in the gastrointestinal tract.
This dual role makes them valuable in reducing mycotoxin absorption while promoting overall animal health.
New research is focused on developing biomarkers that can detect mycotoxin exposure in animals, helping farmers identify contamination early and offering a more accurate assessment compared to traditional feed analysis alone.


This system correlates the presence of mycotoxins in feed with the metabolized products found in the animal’s bloodstream, such as DON-sulfate in chickens and DON-glucuronide in pigs. This provides a comprehensive picture of the mycotoxins’ impact on animal health and performance.
Certain plant extracts, such as those from turmeric and garlic, are being studied for their natural ability to neutralize mycotoxins. These phytogenic additives offer a natural approach to mitigating mycotoxins, complementing conventional binders and detoxifiers.
Biomarkers such as glutathione and other metabolites linked to oxidative stress are also being studied as indicators of mycotoxin-induced damage. These methods are part of broader efforts to improve the precision of mycotoxin monitoring, especially considering challenges like masked mycotoxins and feed sampling errors.
In laboratory testing, liquid chromatography-tandem mass spectrometry (LC-MS/MS) continues to evolve, allowing simultaneous detection of multiple mycotoxins, ensuring more sensitive and accurate results in feed analysis.
Overall, the focus is on integrated solutions that combine multiple strategies for comprehensive mycotoxin management. This includes improved detection, better detoxification products, and a deeper understanding of mycotoxin interaction with animal health.
In modern animal feeding, all these strategies not only safeguard livestock but also protect the food supply, making mycotoxin control a central pillar in sustainable and profitable animal farming.

1
The economic losses attributed to mycotoxin contamination worldwide are substantial, affecting the entire agricultural supply chain, from crop production to animal feed and human health.
Here are some hard numbers highlighting the scale of the problem:
GLOBAL IMPACT ON THE AGRICULTURAL INDUSTRY:
The total economic cost of mycotoxins globally is difficult to quantify due to their complex and widespread impact, but estimates often exceed $5 to $10 billion in economic losses annually.
These losses arise from reduced crop yields, contaminated animal feed, and the associated costs of managing mycotoxin contamination, testing, mitigation, and veterinary expenses.
2
LOSSES IN THE LIVESTOCK INDUSTRY:
The global animal feed industry, which faces high risks from mycotoxin contamination, suffers annual losses of approximately billion.
Mycotoxins like Aflatoxins, Zearalenone, and Deoxynivalenol (DON) negatively affect animal growth, health, and productivity, leading to increased veterinary costs and reduced livestock performance.
3
ECONOMIC IMPACT ON FOOD SAFETY AND TRADE:
Mycotoxin contamination also affects global trade, as stringent regulations in many countries limit permissible levels of mycotoxins in food and feed products.
Exporters face substantial financial penalties, recalls, and product rejections if contamination levels exceed these limits.
In Africa, Aflatoxin contamination is estimated to cause an economic loss of $450 million per year due to rejected crops and food insecurity.
4
CROP-SPECIFIC LOSSES:
For crops like maize, wheat, and peanuts, contamination by mycotoxins can reduce

In summary, mycotoxins pose a significant economic threat across various sectors, from agriculture and livestock production to global trade, with annual losses estimated in the billions.
References are available on our website


As a specialist in mycotoxin risk management in livestock farming for over 20 years , Olmix has brought together all its tools for understanding and managing mycotoxin risk in a single, easy-to-use platform for nutritionists, formulators, technicians, veterinarians and breeders.



DISCOVER THE MYCO’KINGDOM



P.D. Tassis
Farm Animals Clinic, School of Veterinary Medicine, Aristotle University of Thessaloniki, Greece
MYCOTOXINS AS A WORLDWIDE MENACE OF SWINE HEALTH AND PERFORMANCE
Various mycotoxins can be detected in grains used as pig feedstuffs worldwide and their concurrent presence has been widely reported.

Research efforts over half a century have proven that mycotoxins can pose a significant threat to health, performance, and reproductive efficiency of swine.
They are secondary metabolites of certain fungi (genera Aspergillus, Penicillium, Fusarium, Alternaria, and Claviceps)[1] and are produced before harvest of grains (fungi as plant pathogens), or during storage (fungi growing saprophytically).
Some are considered extremely significant for pig health and performance. Namely, aflatoxins (Afs: B1, B2, G1 and G2, deoxynivalenol (DON), zearalenone (ZEN), fumonisins (FBs: FB1, FB2, FB3) and ochratoxin A (OTA) are considered significant for their devastating effects on pig production worldwide.
Other mycotoxins such as T-2, nivalenol, or ergot alkaloids have been suggested as somewhat significant for swine, especially in particular geographical regions[2,3]

Data at a global scale showed that up to 80% of feed and food crops are contaminated with mycotoxins, and that co-contamination of grains with more than one mycotoxin is common[4-6]
According to the European Commission[7,8], the maximum contamination levels in swine feed should not exceed 0.02 mg AFs/kg feed, 0.9 mg DON/ kg feed, 5 mg FBs/kg feed, 0.05 μg OTA/kg feed, 0.1 mg ZEN/kg feed for piglets and gilts and 0.25 mg ZEN/kg feed for sows and fattening pigs, respectively.

The term “biomarker”, which equals “biological marker”, refers to a broad subcategory of objective indications of a medical state that can be measured accurately and reproducibly[9,10]
Therefore, as regards mycotoxins exposure, the predominant characteristic of a biomarker is its accurate and reproducible measurement in biological matrices which could provide information on the total level of exposure to mycotoxins.
Assessment of particular biomarkers provides information on individual exposure, whereas it could assist in the explanation of biological consequences of mycotoxins in animals, observed as toxic effects[11]
Such an approach is increasingly used in monitoring human exposure to mycotoxins[12,13], which is reported as human biomonitoring (HBM), whereas a quite similar animal biomonitoring (ABM) process could be also successful in assessing animal exposure[14] .
Nevertheless, it is true that feed analysis for the presence of mycotoxins has a number of disadvantages when compared to biomonitoring as a diagnostic tool for mycotoxicosis cases. These include facts that may affect the validity of feed analysis results in comparison to the true mycotoxin contamination levels.
Such facts are the uneven distribution of mycotoxins in feed, the risk of improper sampling procedures, the absence of testing of modified or conjugated forms in feed which can convert back to the parent forms and hence contribute to their adverse effects, as well as the lack of information on individual animal exposure from the feed analysis results.
However, a critical point as regards diagnosis of mycotoxin cases in pigs under field conditions, is that clinical signs of mycotoxin exposure can appear when the contaminated feed has already been consumed.


Thus, diagnosis in such cases becomes complicated or even impossible[15]. That is one of the significant advantages of biomonitoring when compared to the classical feed analysis approach[16]
On the other hand, analytical methodology is largely lacking multimycotoxin methods for pig excreta and only a limited availability is found for pig urine or other matrices, while as already reported the exposure to a mixture of mycotoxins through feed in pigs is widely observed[6,15]
Therefore, it seems that the use of biomarkers in mycotoxicosis cases could become a significant key for early understanding exposure levels and for the diagnosis of mycotoxicosis in swine.
The present review wishes to highlight the major biomarkers which could be evaluated in swine mycotoxicosis cases and address possible future prospects.
Differences in metabolic properties and toxicokinetics of each mycotoxin play a significant role in selecting specific biomarkers, whereas their interactions when present together in contaminated feed, have not been fully investigated.
In order to discuss possible utilisation of biomarkers of exposure of the most important mycotoxins for pigs, major aspects of their metabolic and toxicokinetic properties are presented.
AFs are produced mainly by Aspergillus flavus, A. parasiticus and A. nomius and are detected usually in maize, peanuts and cottonseed.
The most common AFs are B1, B2, G1 and G2.
AFB1 is the most significant in terms of toxicity in swine[17]. AFs apart from hepatotoxicity, they have mutagenic, and possibly teratogenic properties in animals.
As regards pigs, 20-50 % of the administered dose of AFB1 is excreted as AFB1 and AFM1 via urine. The amount of AFM1 is 20% of the total excreted dose[18] Previously Luthy et al.[19] had also detected 20% of the administered dose in pig urine and 50-62% in pig faeces.

AFs and, in particular, AFB1 are considered the most potent naturally occurring carcinogens. AFB1 is metabolised predominantly in the liver by a number of cytochrome P450 enzymes, generating several hydroxymetabolites, such as AFM1, AFQ1 and AFP1 and two significantly reactive epoxides, AFB1 exo-8,9-epoxide and AFB1 endo-8,9-epoxide[20-22] .
The exo-epoxide interacts with the guanine part of DNA, resulting in the formation of AFB0-guanine adducts such as AF-N7-Gua which can be used (in urine) as a biomarker of exposure[20,21,23]
Both the endo- and exo-epoxide of AFB1 are toxic and lead to the formation of aflatoxin–albumin (AF-alb) in hepatocytes, which are observable in the sera of exposed animals and humans[20]. These albumin adducts of AFs have been discussed as useful biomarkers of AFs-induced hepatotoxicity[20]

On the other hand, DON as a member of the trichothecene B group, is produced by Fusarium fungi which are one of the most important phytopathogenic fungal genera groups. That group is also responsible for the production of ZEN and FBs[15]
DON’s main mode of action includes the inhibition of protein synthesis by interference with the termination step of the polypeptide chain, which is a part of the elongation step of the protein synthesis that is carried out in the 60S ribosomal unit.


Acute DON intoxications in pigs are clinically observed as signs of abdominal pain, increased salivation, diarrhoea and emesis (3.6-40 mg DON/kg feed) [24], whereas lower DON contamination levels result in reduced feed intake and decreased weight gain, growth retardation, immuno-toxicity, impaired reproduction and development[25] .
The development of an exposure biomarker for DON by quantifying urinary free-DON and a DON-glucuronide combined as total urinary DON was suggested by observations in a rodent model[31]

DON is rapidly (maximal plasma concentration after 15-30 min. of exposure) absorbed in pigs (approximately 90% of ingested dose). DON is distributed to all tissues and can undergo different detoxification pathways, including mainly microbial degradation in the gastro-intestinal tract and secondly a biotransformation in tissues such as the liver[15,26,27].
DON can be metabolised by intestinal microbes to de-epoxy-DON (DOM1) that can be found in plasma or excreta[28]. In pigs, microbial formation of DOM-1 mainly occurs in the distal part of the digestive system, whereas DON is predominantly absorbed in the upper digestive tract, thus partially “avoiding” microbial deepoxidation[28,29]. DON and DOM1 can be conjugated with glucuronic acid and sulphate while in pigs glucuronidation is more common[30].
As regards pigs and the possible use of total urinary DON as a potential biomarker of exposure, it should be highlighted that the major excretion pathway for DON is indeed through urine, according to Prelusky et al.[32] who reported that 54–85% of radioactive labelled DON administered intra-gastrically to pigs was excreted in urine within 24 hours.
It has been reported that about 40–60% of DON in urine is glucuronide conjugated[18,33], whereas the amount of DOM-1 in urine is approximately 2—5% of the DON in urine, and 1–5% of the DON intake[34-37]. A linear increase in urine concentration of DON with increasing dietary DON concentration has been demonstrated[36]. On the other hand, the amount of DON that reaches the faeces is negligible and includes 0.15% of the intake[15]


FBs
The fumonisins are a family of toxins produced mainly by Fusarium verticillioides and F. proliferatum, with FB1 and FB2 as the most frequently observed, whereas FB1 represents approximately 70% of the natural contamination of maize[38]
In contrast to other Fusarium mycotoxins, FB1 is poorly absorbed from the gastro-intestinal tract of pigs with an oral bioavailability of approximately 4% of the administered dose[39,40]
Distribution to tissues has been found predominantly in the liver and kidney, besides the large intestine and brain and to a smaller extent lung, heart and adrenal gland.
FB1 also undergoes enterohepatic circulation, which extends its biological elimination half-life. Its metabolism takes place by microorganisms in the small intestine and results in the formation of fully hydrolysed FB or aminophenol (AP) and partially hydrolysed FB1 (PHFB1).
FB1 is mainly excreted via faeces of pigs (>90%) with maximum concentration at 48h after administration and to a lesser extent via urine (± 5%) as FB1[15].
FB1 has a sphingoid backbone and can inhibit ceramide synthase, resulting in the modulation of two physiologically important precursors in sphingolipid production: sphinganine (Sa) and sphingosine (So), thus inducing accumulation of sphinganine (Sa) and sphingosine (So) in tissues, serum and urine[41] and an increase in the Sa/So ratio.
That mechanism has been recognized as the causal pathway for FBs toxicity. This leads to reduced nutrient absorption, anorexia, decreased daily weight gain and hepatotoxicity in pigs[15]
Signs of encephalopathy and cardiac dysfunction with pulmonary oedema have been observed after administration of FB1[42]
According to EFSA recommendations (Table 1) sphinganine/sphingosine ratio in blood should be held as the gold standard of FBs biomarkers in swine.


Aspergillus species mainly, and Penicillium species can produce ochratoxins with OTA having major nephrotoxic properties.
OTA is passively and rapidly absorbed from the stomach and the proximal duodenum after oral ingestion. Approximately 66% of oral administered OTA is absorbed in pigs[15,43,44].
OTA in the systemic circulation has a high affinity for plasma proteins, especially to albumin, therefore 99% of the absorbed fraction will be bound to plasma proteins in pigs (<0.2% OTA free fraction in serum).
Thus, the absorption of OTA from the gastro-intestinal tract is stimulated resulting in prolongation of its presence in the body, slowing both its biotransformation and excretion half-


OTA can be metabolised in the kidney, liver and intestines whereas major metabolic pathways include hydrolysis, hydroxylation, lactone-opening and conjugation.
OTA can undergo phase II metabolism with the formation of glucuronic acid and sulphate conjugates, whereas only the glucuronic acid conjugates have been detected in the bile of pigs[15].
The metabolite OTalpha (OTα) is formed by the cleavage of the peptide bond in OTA and is considered as a nontoxic product[46]
OTA largely remains unchanged after ingestion in pigs and can accumulate in the meat and organs due to high bioavailability, limited conversion rate into OTalpha and long half-life.
OTA is excreted via urine (via tubular secretion) and faeces (via biliary excretion). However, the occurrence of OTA reabsorption from the urine by all nephron segments has been reported, resulting in retarded excretion and accumulation of OTA in the kidney, where it exerts its main toxicity[44,47].

ZEN is a macrocyclic β-resorcylic acid lactone with structural similarity to naturally occurring oestrogens, thus reproductive disorders in swine have been predominantly linked to ZEN toxicity, following the binding of ZEN to oestrogen receptors.
Hyperestrogenism in pigs observed at doses of 0.06 and 0.15 mg/kg feed includes signs of reddening, hyperaemia and oedematous swelling of the vulva, enlargement of the uterus with cyst formation on the ovarian and enlargement of the mammary glands, whereas vaginal or rectal prolapse in such cases has been also reported.
Gilts are significantly sensitive to the toxic effects of ZEN since their concentrations of 17-β-oestradiol are lower compared to sows.
On the other hand, signs in boars include atrophy of the testes, reduction of the concentration of spermatozoa and oedematous swelling of the preputium and mammarian complex. Moreover, embryotoxic and teratogenic properties of ZEN have been described[15,48]
ZEN is rapidly absorbed after oral exposure with an oral bioavailability of approximately 80% of the administered dose in pigs[48]
ZEN is metabolised via phase I and II reactions. ZEN metabolism in pigs includes a phase I reduction of ZEN, by the microbial organisms in the gastrointestinal tract of pigs and by 3α or 3β-hydroxysteroid dehydrogenases in the liver, oocytes and intestinal mucosa, to predominantly Myriad Pro α-zearalenol (α-ZEL) and at a lower level to β-zearalenol (β-ZEL)[15, 49], while also α-zearalanol (α- ZAL), β-zearalanol (b-ZAL) and zearalanone (ZAN) can be formed.
The α-ZEL is considered a bioactivation product as a more potent metabolite[2,49]. ZEN and its phase I metabolites can undergo phase II conjugation with glucuronic acid and sulphate (through catalysis by by uridine 5’-diphospho-glucuronosyltransferases and sulfotransferases)[48]. Both glucuronidation and sulfation are considered as detoxification pathways[15]

As regards ZEN possible biomarkers of exposure, Olsen et al.[50] reported that 15.6% of ingested ZEN from 5 mg/kg feed was excreted in urine as ZEN (mostly as glucuronide conjugates) and α-ZEL within 8 h.
Similarly, Zöllner et al.[51], estimated that approximately 14% of ZEN intake was excreted in urine either as parent toxin or as metabolites within 8 h.
However, Dänicke et al.[53] reported 30% urine excretion of ZEN within 6 h after female pigs had been given a single bolus of 1 mg ZEN/kg body weight, whereas up to 70.4 % of the dose was excreted in urine within 72 h.
Taken together, 40% of the administered dose of ZEN can be recovered in urine (26±10%) and faeces (14± 3%) in pigs, as ZEN or its metabolites at 48h after administration[15].
Faecal samples have been shown to contain ZEN and α-ZEL, which are also present in plasma, whereas in urine ZEN and ZEN-GlcA are detected[51,52].
As previously suggested biomarkers are defined as substances measured in biological systems linked to effect, exposure or susceptibility[53], while the measurement of these markers in biological matrices is known as biomonitoring.
Biomonitoring has two major applications which include exposure assessment and in vivo efficacy testing of candidate mycotoxin detoxifiers[15]. Biomarkers can be categorised based on their characteristics and use as follows[15,54]:
Biomarkers of exposure: They provide evidence of exposure of individuals to xenobiotics (such as mycotoxins) through an estimation of the concentrations of these compounds or their metabolites in biological matrices. They are often the mycotoxin itself or/ and its phase I and II metabolites or interaction products.

Biomarkers of effect: They are connected with the measurement of biochemical, physiological, or behavioural alterations in the organism which can be attributed to a possible or established health effect.
Biomarkers of susceptibility: They are used as indicators of an ability (inherent or acquired) to respond to exposure to xenobiotics.

Based on the above-mentioned differences among species and metabolic/toxicokinetic properties of various mycotoxins, the European Food Safety Authority (EFSA)[55] has recommended endpoints/biomarkers (Table 1) as proper validation endpoints of the efficacy of a feed additive which claims adsorbing or modifying capability against mycotoxins.
The selection of the appropriate endpoint should be based on the mycotoxin and target species, whereas the availability of sensitive analytical methods validated for the specific matrices should be taken into account.
Aflatoxin B1
Aflatoxin M1 in milk/egg yolk.
However, it has been suggested that the above-mentioned biomarkers may not always be the most optimal for each mycotoxin[15]
DON concentrations in blood serum could be a relevant biomarker for exposure, but on the other hand, DON undergoes an extensive phase II biotransformation to DON-GlcA in pigs, therefore, that metabolite could be considered as more precise biomarker for exposure than DON itself[30]
Furthermore, even though biomarkers for exposure have been defined for particular mycotoxins in some animal species, the identification of the suitable biomarker for each mycotoxin in a certain species and specific biological matrix is often missing[15]
The most widely used biological matrices are urine and blood, whereas biomarkers can be also detected, in hair, saliva and faeces.
Fumonisins B1 + B2 Sphinganine/sphingosine ratio in blood, plasma or tissues.
Ochratoxin A Ochratoxin in kidney (or blood serum).
Zearalenone Zearalenone + a- and b-zearalenol in plasma. Excretion of zearalenone/metabolites.
Deoxynivalenol DON/metabolites in blood serum.
Table 1 Recommended relevant endpoints/biomarkers for substances claiming ability to reduce contamination of feed by mycotoxins[55]

Urine, plasma and faeces can be collected easily in living pigs, whereas bile or organs can be also useful matrices, but they are collected post-mortem. Thus, biomonitoring on easily accessible matrices, which can be collected through non-invasive and non-stressogenic processes, is gaining more interest in recent years.
Dried blood spots (DBS), hair and saliva are among such matrices, which have reduced storage and transport requirements. Until today methods are available for mycotoxins in DBS and hair of animals and humans, whereas for the detection in saliva they are not fully available[15].
Assessment of DBS for multimycotoxin biomarker analysis in pigs has been previously reported[56]. In that study, a method was developed and validated for the determination of 23 mycotoxins and their phase I and II metabolites in DBS of pigs, whereas under in vivo exposure conditions, a strong correlation was observed between plasma and DBS concentrations. Findings supported DBS as an interesting micro-sampling technique for use as a non-invasive biomonitoring system of mycotoxins exposure in swine.
Moreover, recent findings suggested that circulating microRNAs (MiRNAs: small non-coding RNAs) have remarkable potential to serve as indicators for pathological processes in tissues, such as the case of toxic effects induced by ZEN[57] and DON[58], OTA and AFB1[59].
MiRNAs can be viewed as characteristic biomarkers whose levels can be directly measured in serum, urine, tissues and saliva[57,59].
Findings through transcriptomics approaches indicated that ZEN can induce dose-dependent alterations of several uterine MiRNAs, whereas such effect was partly reflected in serum of exposed animals, thus providing evidence for a novel mycotoxin biomarker discovery[57]
Evaluation of DON-induced changes in the MiRNAs expression in porcine liver, jejunum and serum, proved a time dependent serum MiRNAs response to DON which declined after removal of contaminated diets.

Based on those findings four MiRNAs were identified as candidates for the detection of DON toxicity in porcine serum[58]
It seems that the use of biomarkers involved in critical signalling pathways and connected to the mode of action of mycotoxins may help predict their potential toxicity and the progression of associated mycotoxicosis, as well as to develop effective biomonitoring approaches[60].
Previous studies in pigs have provided evidence of multiple biomarkers of exposure to mycotoxins which correlate with the mycotoxins ingestion levels received:
The total DON concentration in serum and the sum of ZEN and metabolites in urine both have correlated well with the intake of the toxins from the feed[61].
DON concentration in serum and DON and DOM1 concentrations in urine increase in a dose-response-related manner as dietary DONconcentration increases[52]. Therefore, they are suitable biomarkers of exposure in pigs, whereas DON-GlcA in serum could be considered as a better biomarker for exposure[14] .
DON-glucuronide (DON-GlcA) and ZENglucuronide (ZEN-GlcA) in plasma, DON and ZEN-GlcA in urine and, ZEN in faeces (late excretion due to enterohepatic circulation of ZEN) have been reported as optimal biomarkers for DON and ZEN[54].
According to the review by Tkaczyk, and Jedziniak[14], ZEN and its metabolites
α- and β-ZEL in urine, as well as ZEN and its metabolites: α-, β-ZEL, and ZAN in faeces, or the plasma levels of GlcA metabolites (phase II metabolites) of ZEN, α-ZEL, and β-ZEL can also be suitable biomarkers of exposure in pigs.
Both plasma and urine FB1 levels are considered as adequate biomarkers of early exposure to low dietary levels and plasma is recommended under conditions of prolonged exposure (>14 days) in pigs. A correlation between FB1 in feed and hair has been also reported but was lower compared to urine and plasma[62].
The disruption of the sphingolipid biosynthesis can also be used as a biomarker for FB1 exposure, though it can be considered also as a biomarker of effect. The ratio Sa/So will increase in serum and tissues in a dosedependent manner[63,64] .
Measurement of AFB1-lysine concentration in serum demonstrated that longer exposure to AFB1 results in higher levels of AFB1-lysine, thus that the lysine adduct might be a good biomarker for long term AFB1 exposure[65]
In addition, AFB1-N7- guanine and AFM1 in urine have been also suggested as possible biomarkers for AFB1 exposure in pigs[15]. Tkaczyk et al.[14] identified AFB1, AFM1, and AFB2 as biomarkers of AFB1 exposure in the urine of pigs.
The concentrations of OTA in blood and urine have been reported as good markers for OTA contamination in various organs[15]

Several issues should be further clarified through research on the field of mycotoxicosis such as the occurrence and fate of modified or masked mycotoxins, as well as the interactions among mycotoxins when present as mycotoxin mixtures in contaminated pig feed.
The use of biomonitoring and the assessment of respective biomarkers seems a promising tool in understanding such complex procedures and their effects on health and performance of swine.
Early diagnosis of mycotoxicosis under field conditions based on biomarkers assessment in biological matrices should be well connected with respective feed contamination levels in order to lead to proper and timely performed counteracting measures regarding contaminated feed and the animals.
It should be stated that accurate – sensitive methods (at reasonable cost) of quick biomonitoring testing in biological matrices, received with minimal animal restraint should be the focus of the future research efforts on the field of mycotoxicosis diagnostics and especially in cases of combined mycotoxicosis exposure.
Nevertheless, taking into account the complexity of sampling preparation for such analysis and the concurrent presence of multiple mycotoxins with different toxicokinetic properties, it seems that the preparation of such technology would not be an easy task.
References upon request.

Biomarkers of mycotoxins exposure in swine DOWNLOAD ON PDF

Tainara
Ciuffi E. Dornelas
Doctor in Animal Production Technichal Coordinator of nutriNews Brasil
The investment applied to research involving poultry farming, along with the productive organization of the sector, has granted Brazil a prominent position in the global poultry production scene and on consumers’ tables.
In the year 2023, the country exported 5.138 million tons of chicken meat, reaching new records as the first chicken meat exporter and maintaining its position as the second largest producer of chicken meat in the world, only behind the USA. The states in the southern region of the country were responsible for more than 70% of the chicken production (ABPA, 2023).

All this success would not have been possible without research involving the nutrition and genetics of poultry. Only through such research have we achieved animals with a better nutrient intake/ conversion into muscle tissue ratio, better finishing in premium cuts such as thigh and breast, but with more refined physiological and nutritional needs, thus requiring further research to understand these phenomena.
Nutrients are not only necessary for metabolic functions, but they also play a role in information or signaling systems within cells.
When a system transmits information, the signal must have a sensor or receptor to decode and transmit the information.
Additionally, receptors, which are cellular proteins that receive and transmit information, convey these signals to the cell nucleus through transduction mechanisms capable of reprogramming the cell to adapt to changes in environmental conditions. This can include changes in gene expression (transcription, translation), the stability of RNA and messenger proteins, and protein activity.
One way to understand how nutrients act in an integrated manner within an animal’s body is at the molecular level. Thus, nutrigenomics is responsible for explaining the interaction between genes, diet, environmental factors, and gut microorganisms, and how this association can affect the digestion, absorption, and excretion of nutrients, tissue deposition, and animal metabolism. This is just one of the areas of genomics, which also involves metabolomics, proteomics, and transcriptomics.
Since the completion of the sequencing of the avian genome, various studies involving nutrition and its effects on the gene expression of these animals have been conducted.
Dietary protein is necessary to provide essential amino acids, which the body is not able to synthesize. After ingestion and degradation, the transport of these nutrients out of the epithelial cells is mediated by transporters located in the basolateral membrane.

Amino acids are absorbed as free amino acids or peptides by a variety of transporters with specificity for acidic, basic, and neutral amino acids and small peptides.
The composition of the diet can help animals overcome the environmental challenges they face daily. Since the diet is largely composed of corn and soybean meal, it is necessary to supplement it with amino acids.
Methionine is a sulfur-containing amino acid that was isolated in 1922 by pathologist John Howard Mueller from the hydrolytic products of casein, a fraction of a new sulfur-containing amino acid required by the bacteria Streptococcus hemolyticus for its growth.
Thus, by understanding that amino acids are constituents of proteins, we recognize their importance for the development of poultry, as they are responsible for modulating different pathways that maintain the physiological state of the bird.
In poultry nutrition, it is impossible to think about amino acids without the first one mentioned being methionine. Beyond being a tissue builder, methionine is also a great ally against damage caused by heat stress.
In 1928, the new amino acid had its chemical formula identified as α-amino-γ-methylthiobutyric acid by George Barger and Frederick Philip Coyne, who suggested the shorter name methionine to John Howard Mueller, in reference to its characteristic group.

The forms of methionine available as the most commonly used synthetic commercial sources in animal feed are:
DL-methionine (DL-Met) in powder form;
DL-methionine liquid as sodium salt (DL-methionine-Na);
Methionine hydroxy analog (MHA) in powder form;
As calcium salt (MHA-Ca);
Liquid as free acid (MHA-FA).
Methionine has various functions in the animal body, the primary one being its participation in protein synthesis. It is also a precursor of cystine, so as long as methionine supplementation is adequate, cystine supplementation becomes unnecessary.
Methionine can be an alternative source of cystine in a non-reversible process, playing an important role in the structures of various proteins (immunoglobulins, insulin), by linking several polypeptide chains via disulfide bridges. It is also used in the formation of skin and feathers, which explains the high demand for these amino acids in birds.

Methionine is an important limiting amino acid and an essential nutrient in birds. It can promote the mobilization of lipids to provide energy for growth and protein deposition, regulating nutrient metabolism. Additionally, methionine enhances antioxidant capacity and immunity.
In Part II of the next edition, the action of methionine on antioxidant status will be discussed.

Going one step beyond in animal nutrition means ceaseless research and development. Going one step beyond means anticipating developments in the livestock industry and offering the highest quality products and services. Going one step beyond means total commitment to overcoming all our customers’ challenges.
Cinta Sol1, Gerardo Villalobos1, Felipe Horta1, Jihwan Lee2 and Woo Kyun Kim2
1Nuproxa Switzerland Ltd.
2Department of Poultry Science, University of Georgia, USA
Coccidiosis, a disease caused by species of the genus Eimeria, is one of the most economically devastating diseases in the poultry industry.
The result of infection caused by this parasite can lead to variable clinical signs, from subclinical diarrhea to more serious cases with increased mortality.
The low weight gain and poor feed conversion generated by this condition cause significant economic losses in a combination of direct and indirect costs:







Direct costs:
Treatment and Prevention: The cost of anticoccidial drugs and vaccines used to prevent and treat coccidiosis can be substantial. This includes both the cost of the products and the labor required to administer them.
Veterinary services: Expenses related to veterinary services for diagnosis and management of coccidiosis outbreaks contribute to the overall cost increase.

Indirect costs:
Low performanc: Infected birds generally show a decrease, not always noticeable, in performance, leading to lower overall productivity.
Mortality: Severe cases of coccidiosis can lead to high mortality rates, resulting in direct losses in the poultry herd.
Decreased egg production: In layers, coccidiosis can cause a significant drop in egg production and quality, affecting profitability.
Development of resistance: The development of resistance to anticoccidial drugs creates the need for continuous development of new solutions and protocols, leading to a slow and costly process.
Research and Development:
Significant investments are made in research to develop better management practices, vaccines and alternative treatments.

Traditionally, the prevention and control of coccidiosis has been based on chemoprophylaxis, anticoccidial products (coccidiostats and coccidicides) and the vaccination of birds with selected Eimeria oocysts. .
However, there are several concerns associated with their use:
Development of resistance: The continuous and widespread use of anticoccidials has led to the emergence of drug-resistant coccidial strains. This resistance reduces the effectiveness of existing treatments and makes it difficult to manage the disease.
Management strategies: To combat resistance, strategies such as the rotation of different classes of anticoccidials, the use of combination therapies and the integration of non-chemical control measures are recommended.


Risks to human health: Residual traces of anticoccidials in meat, eggs and other products of animal origin can pose risks to consumer health; safety intervals are needed to avoid this risk.
Regulatory standards: Regulatory agencies establish maximum residue limits (MRLs) for anticoccidials in food products. Ensuring compliance with these standards is crucial for food safety.
Contamination: Anticoccidials can enter the environment through animal waste, contaminating soil and water. This can affect non-target organisms and contribute to the wider issue of antimicrobial resistance.
Cross-contamination: To avoid crosscontamination of food with different anticoccidials, it is very important to properly clean and disinfect the facilities.
Mitigation measures: Proper waste management and treatment practices are essential to minimise environmental contamination.
Excessive and improper use: Overreliance on anticoccidials can lead to poor health outcomes, accelerated development of resistance and reduced animal welfare.
Alternative Approaches: A Incorporating alternative nonchemical approaches, such as polyherbal products, can support animal performance and health, as well as reducing dependence on and resistance to traditional anticoccidials.

Regulatory compliance and monitoring:
Ensuring compliance: Effective monitoring and enforcement of regulations regarding the use of anticoccidials is crucial. This includes compliance with safety intervals before slaughtering animals or marketing their products.
Global Standards: Harmonising global standards and practices can help mitigate the risks associated with international trade and guarantee consistent food safety and animal health practices.

To address these concerns, a multifaceted approach involving regulatory oversight, industry practices and scientific research is needed to ensure safe and cost-effective strategies to control avian coccidiosis while protecting public health, animal welfare and the environment.
In response to growing concerns about the use of drugs, synthetic additives and resistance in poultry production, there is increasing interest in natural phytogenic supplements, which aligns with the growing demand for organic animal products in the global market.
In this context, a study was carried out at the University of Georgia, USA, to investigate the effects of NUXASAN 500™ (Nuproxa Switzerland, Ltd.), a product of natural origin, as an alternative strategy to synthetic anticoccidials.
The work evaluated its effect on performance, intestinal integrity, oocyst count, expression of pro-inflammatory cytokines and on the antioxidant system at the level of the intestinal mucosa in broilers experimentally challenged with Eimeria spp.
A total of 288 one-day-old male Cobb 500 broilers were randomly assigned to 3 treatments with 8 replicates per treatment and 12 birds per cage for 28 days.
The treatments were: Negative Control, NC (basal diet, not challenged), Challenge Control, CC (basal diet challenged with Eimeria spp.) and CC + 500 ppm NUXASAN 500™ (NUX).
Birds in the CC and NUX groups were orally inoculated with 62,500 oocysts of E. acervuline, 12,500 oocysts of E. maxima and 12,500 oocysts of E. tenella on day 14, and the NC group was orally inoculated with the same




Table 1. Performance results at 28 days.
NC, Negative Control; CC, Challenge Control; SEM, standard error of the mean.
Table 1 shows the performance results at 28 days, where the birds in the NUXASAN 500™ group were significantly heavier, with lower FCR and mortality.
As shown in Figure 1, the use of NUXASAN 500™ achieved a significant reduction in the excretion of oocysts (P<0.05) of E. tenella at 6-7-8-9 days post-inoculation (DPI), E. maxima at 7 and 9 DPI and E. acervulina at 6 DPI (P=0.055).
The CC group also had numerically the highest incidence of severe lesions and an average score of high lesions in the duodenum, jejunum and caecum. NUXASAN 500™ mitigated the incidence of severe and very severe lesions in the duodenum and caecum caused by Eimeria spp.
Figure 1. Oocyst sheding counts in feces of broilers challenged with Eimeria spp. CC, Challenge Control; NUX, NUXASAN 500™. *shows significant differences at p<0.05.
Excretion of oocysts, x105




Figure 2. Effect of treatments on intestinal lesion score at 6 DPI in broilers challenged with Eimeria spp. (from 0 = no macroscopic lesion to 4 = very severe lesion, numerous blood clots, characteristic colour and odour). "a-c" different letters between columns shows statistical differences p<0.05.



NC, Negative Control; CC, Challenge Control; NUX, NUXASAN 500™


In gene expression analyses, challenge with Eimeria spp. increased (P<0.05) the gene expression of claudin 1 (CLDN-1) and proinflammatory cytokines - interleukins IL-1β, IL-6, TNF-α and IFN-γ in the jejunum compared to the NC group; in contrast, in NUXASAN 500™ group, the gene expression of CLDN-1 and IL-1β, TNF-α in jejunum was reduced (P<0.0001) and the expression of the enzyme glutathione peroxidase (GPx) in the jejunum was numerically increased compared to the CC group
The economic impact of coccidiosis in poultry is significant, affecting both large-scale commercial operations and small-scale producers.
Effective management strategies, including good biosecurity practices and the development of alternative treatments, are essential to mitigate these costs and ensure the sustainability and profitability of the poultry industry.

Supplementation with 500 ppm NUXASAN 500™ effectively mitigated the negative effects caused by the challenge with Eimeria spp., proving to be an efficient nutritional strategy for improving the performance and intestinal health of broilers challenged with coccidiosis, as well as improving the profitability of the system as a whole.
Effects of NUXASAN 500™ on the performance and intestinal health of broilers challenged with Eimeria spp. DOWNLOAD PDF


Edgar O. Oviedo-Rondón
Prestage Department of Poultry Science, North Carolina State University. Raleigh, NC

Guidelines for nutrient recommendations are valuable sources of information for poultry and animal nutritionists worldwide. Currently, several nutrition recommendations are provided by primary breeding companies and industry or academic groups.


The Spanish Foundation for the Development of Animal Nutrition (FEDNA) published the NORMAS FEDNA for poultry (2018), The Federatie Nederlandse Diervoederketen has the CVB Table Booklet Feeding of Poultry (2018), and Rostagno and collaborators presented recently the 5th edition of The Brazilian Tables for Poultry and Swine (2024).
However, for many decades, the National Research Council (NRC) report of the United States of America was one of the cornerstone references for poultry nutritionists worldwide. The National Academy Press (NAP) published these NRC reports almost every ten years until 1994, when the last one, the 9th revised edition, was issued.
The name of this publication will change since the NRC is now part of another institution. In 2015, the NRC merged with the National Academy of Engineering and the National Academy of Medicine to become the National Academy of Sciences, Engineering, and Medicine (NASEM).
These three private, nonprofit organizations provide the U.S. government expert advice on science, health, and engineering. However, their publications only use the name NASEM. For example, in 2021, the NASEM produced the consensus study report of the eighth revised edition of Nutrient Requirements of Dairy Cattle, and the NRC name disappeared in that publication.
In 2016, an ad hoc committee was created with professors from several American and Canadian Universities and Dr. Gonzalo Gonzalez Mateos from Spain to review the scientific literature on poultry nutrition and make recommendations on nutrient requirements.
On July 15, 2024, this Committee presented an overview of its report during the Informal Nutrition Symposium, held annually during the Poultry Science Association (PSA) Meeting.
The present article is based on the information published by the members of this Committee in the PSA meeting abstract book and notes taken during their presentations. The video records of this symposium are available on demand on the PSA website for those that attended the meeting and by November they will be available to all PSA members.
The final printed report should become available to the public in fall 2024, and more information will be available on the NAP website.
https://nap. nationalacademies.org/ VISIT WEBSITE
As it is a tradition, in all these reports of nutrient requirements for all animal species, the 2024 poultry report builds on the 1994 report and those that preceded it. This time, Committee members reported that all chapters had been expanded considerably, and more details were provided for each nutrient and poultry species.
The committee’s recommendations were expressed as the minimums based on the relevant research available. This report includes new chapters for adjusting formulated levels to avoid nutrient deficiencies or excesses based on the ingredients fed and their digestibility or bioavailability. Chapters on feed processing, feed additives, gut microbiota, gut health, and other current topics were mentioned.
The Committee accepted that, in some cases, only tentative recommendations based on speculative guidance were provided due to insufficient information or recent studies specifically designed to determine nutritional requirements.
Computer models were used to estimate the nutrient requirements of broilers and layers. However, this Committee decided that the models used are in the early stages of development. Consequently, they recommended conducting new research to further develop and validate them before providing wide applications or publishing details about them.
In this 10th revised edition, the energy requirements for maintenance and production were defined as nitrogencorrected apparent metabolizable energy (AMEn). The Committee decided that net energy information is still incomplete to develop recommendations.
A better description of fiber and carbohydrates and their impact on digestibility and gut microbiota were included in this report. The data was obtained from research conducted primarily with cereals and soybean meals. However, it is recognized that the utilization of feedstuffs with high fiber content in poultry diets has increased, a trend that will continue.
Consequently, in this new edition, the NASEM report paid more attention to evaluating more accurately the energy content of ingredients that vary in composition and physicochemical properties.
The amino acid chapter implemented new sections that included sources of amino acids, bioavailability of D-amino acids, amino acid analysis of feedstuffs and physiological fluids, amino acid deficiencies, and empirical methodology to estimate amino acid requirements and ratios in poultry. Additionally, this publication explained the classification of amino acids, factors causing variation in amino acid requirements, unique amino acid relationships, imbalance, antagonisms, and toxicity.
The vitamin and mineral chapters were expanded to include descriptions of functions, deficiency, and toxicity. Additionally, the report introduced for the first time the concept that vitamins and minerals do have effects when included above the minimum requirement. The report also contains additional background on using vitamins and minerals in poultry diets.
The nutrient requirements for broilers, broiler breeders, laying pullets and hens, turkeys, and minor species like ducks, geese, quail, and partridges are presented in separate chapters that were all expanded. However, there was a consensus that more research is needed on all species.
The broiler chapter incorporated amino acid, mineral, and vitamin requirements reported on a weight basis.
Still, digestible amino acids were expressed both as a percentage of the diet and on an intake basis (milligrams/day). Regression equations were proposed to estimate the digestible lysine requirements. These equations were obtained by summarizing empirical data.
All other amino acid requirements were determined based on the digestible lysine requirements and applying digestible amino acid ratios from the literature. This methodology was applied due to the data gaps related to amino acid requirements for some broiler body weights.
Digestible lysine requirements of male and female broilers were provided from data estimated by factorial models that included the needs for maintenance and body protein accumulation.
More gaps in knowledge were observed in broiler breeder nutrition, especially in male nutrient needs. We will have to wait to review the report to understand how this information was managed and what recommendations were provided for breeders.
More details about nutrition function and the rationale for changing nutrient levels in table-egg-laying hens were provided. Models were used to estimate amino acid recommendations for pullets and laying hens.
This Committee increased the information on the turkey meat production system. It compiled the results of new research on essential amino acids, calcium, and available phosphorus for growing turkeys. However, no information was found on turkey breeder nutrition, and due to the significant gaps, modeling is recommended.
The amino acid and mineral recommendations of white Peking ducks were updated except for isoleucine and leucine. But, levels of magnesium, sodium, and manganese were not updated due to a lack of new research.
Data produced in Asia helped to update recommendations for most nutrients required by growing geese, but no information was found for laying geese. Brazilian research results were used to update Japanese quail and meat-type breeds.

This Committee recognized many knowledge gaps and recommended the following:
To develop new research on speciesspecific digestible amino-acid values for diverse feedstuffs.
To continue the development of dynamic computer models to predict nutrient requirements.
Standardize the methodologies to determine energy needs and feedstuff energy content.
To enhance the research examining poultry nutrition’s environmental impacts and sustainability.
To evaluate the nutritional impacts of feed restriction in broiler breeders and alternatives to control their body weight during rearing.
We will have to wait a few more weeks to review this study report this fall and assess the data compiled for practical use in poultry nutrition. Our next article in the December issue will bring some of these results to our readers.
Preview of the 10th Revised Edition of The Nutrient Requirements of Poultry (2024) DOWNLOAD ON PDF
























Dr. Susanne Rothstein & Sarah Gravemeyer
Biochem
Trace minerals are essential components of layer and breeder diets, and their functions in the organism cannot be compensated by other dietary components. Today it is known that the elements zinc (Zn), manganese (Mn), copper (Cu) and iron (Fe) are relevant for several production parameters and animal well-being:
They are part of a variety of enzymes involved in the immune system, wound healing, egg production, reproduction, as well as integrity of the skin and skeletal system.
Moreover, they have a key role in the antioxidative system keeping the animal healthy - especially under stressful conditions, like heat stress.

Zn is important for the synthesis of the structural proteins collagen and keratin in bones, cartilage, foot pads, skin, beak and feathers. But also, Mn and Cu play an important role in the formation and integrity of these body tissues. Regarding eggshell formation, Zn is a cofactor for the fixation of calcium carbonate and Mn is important for the mechanical properties and ultrastructure.
Moreover, Cu catalyzes the crosslinking of elastin and collagen during the egg building process, and a deficiency can lead to eggshell deformities. Fe is a constituent of hemoglobin and myoglobin. It is essential for proper oxygen transport and storage, protein metabolism and energy supply, most relevant for the chick’s development.



Using chelates in combination with inorganic trace mineral sources or in partial/full replacement has been shown to be beneficial for egg production and eggshell quality, which are essential for the economic success of a layer farm –especially with increasing age of the hen.
A good eggshell stability is equally important in chicken breeding as it is crucial for a good embryo development, especially during the last phase of incubation.
Weeks 25-27
Weeks 19-55 Inorganic Inorganic + Glycine chelates
Figure 1: Effect of adding glycine chelates (E.C.O.Trace®) to the diet on egg production compared to the previous production cycle with only inorganic trace minerals in the diet (field trial, n ~ 53,000 per group) (Biochem, 2019).
Feeding glycine chelates to older laying hens (74 ± 2 weeks) slightly improved eggshell quality already after 2 weeks, demonstrated by a higher eggshell strength and eggshell thickness (Figure 2). This rapidly visible effect can be explained by the high demand of older laying hens for highly available trace minerals.
Sulfates Sulfates + Glycine chelates
Chelates have been shown to support the overall health status of layers and breeders, e.g., birds can profit from higher blood serum concentrations of immune cells (like leukocytes) and an improvement of the antioxidative status.
Another important parameter of animal welfare is footpad health, which is known to be better when using glycine chelates in combination with inorganic trace minerals (Figure 3)
In addition, it is well known, that birds fed chelates demonstrate a higher bone mineralization and an overall improved appearance, for example by a better feathering.

Finally, various studies showed that chelates have positive effects on longevity and can reduce bird’s mortality in the flock. During the above-described field trial (Biochem, 2019) mortality was reduced from 3.7 % (inorganic) to 2.4 % (inorganic + E.C.O.Trace®) during weeks 19-55. In addition, laying hens fed glycine chelates could be kept in the house 8 weeks longer than usual.
Numerous studies proved advantages of feeding chelated Zn, Mn, Cu and Fe on fertility of breeding hens and breeder roosters reflected by an increased number of fertile eggs. Hatchability of fertile eggs is of high economic relevance and has been proven as well to be positively affected by the implementation of chelated trace minerals in hen diets.




Figure 3: Scoring results of foot pad dermatitis in broilers after 6 weeks of fattening period (n=100) with only inorganic trace minerals or a combination of inorganic trace minerals with glycine chelates (E.C.O.Trace®) in a field trial (Biochem, 2021b).
Trace mineral supply is a crucial factor in layer and breeder feeding. An optimal supply of modern genetics can especially be ensured by using organic sources, like glycine chelates, without increasing excretion levels. Adding chelates to diets has positive effects on egg production and shell stability, longevity as well as mortality, fertility, hatchability and chick quality. Consequently, trace mineral chelates can be seen as a useful tool to improve economy as well as ecology of egg and chick production.
References are available upon request.
layer and breeder performance via trace mineral nutrition
Moreover, supporting a high trace mineral supply to the egg yolk via nutrition of the hen, improves humoral immune response, protection from oxidative damage as well as gastrointestinal development of chicks. In addition, it has been shown that feeding chelates affects embryo live weight, mortality, and bone mineralization and therefore bone stability positively.


YELA PROSECURE is a specifically designed hydrolyzed yeast. Produced with a controlled hydrolysis process ensuring a consistent product composition, YELA PROSECURE offers highly digestible and functional nutrients that support animal performance, digestive care and feed palatability while contributing to the feed protein balance.

We interviewed Gonzalo González Mateos, Full-time Professor at the Polytechnic University of Madrid, an international reference in animal nutrition.
What are the key points to consider in the post-weaning period to ensure a correct adaptation of the piglets, always prioritizing the control of diarrheal processes?
Increased physical activity (fighting for survival), thermoregulation, stress, and boosting immunity are important factors to consider because they represent a considerable energy expenditure for piglets in the postweaning period, with the added problem of low feed intake in this problematic phase.




In this regard, the drastic and sudden separation from the mother and littermates, the change of environment, and the mixing of litters create a great deal of stress for the piglet, weakening its defenses and diminishing its ability to adapt. If we add to this the lack of regulation of body temperature, we find ourselves with weak animals, unable to defend themselves against more aggressive pen mates.
Under these circumstances, seeking food or a water source is not a priority for the piglet.
The expenses caused by stress and the mechanisms of immunity and defense are very important, as the piglet has to dedicate the few nutrients it consumes to “produce” acute phase proteins (APP) with higher proteins production in the liver and lower in muscle.
The catabolism of muscle proteins is an important topic to consider. If the animal does not eat enough, APP are produced from muscle proteins, but the profile of both is very different, so the efficiency of the process is reduced. That is, one gram of muscle protein does not result in one gram of APP.
In relation to protein metabolism, it is important to remember that, during the post-weaning period, muscle growth is not a priority for the piglet.

What happens with feed intake in the post-weaning period?
The piglet eats little or nothing in the first hours after weaning, especially if weaning occurs at 21 days of age.
The piglet’s goal at this stage of its life is to ensure that the intake minus the energy and protein expenses necessary for physical activity, such as fighting, thermoregulation (cold), stress (lack of consumption), and immunity (health defense), is not negative. That is:
INTAKE - EXPENDITURE > 0
It is essential that expenditures do not exceed intake, but if feed consumption is limited, this is difficult to achieve.
It is estimated that up to 25-30% of piglets weaned at 21 days of age do not eat anything during the first 20 to 24 hours post-weaning.
If the piglet does not eat, the production of hydrochloric acid and digestive enzymes is reduced, as what is not needed ceases to be a priority.
The problem is not stress itself. What happens is that nature is wise and does not produce digestive enzymes or hydrochloric acid because they require a great deal of energy, and if the animal does not eat, it does not need to be prepared to digest feed and therefore saves energy.
Why produce hydrochloric acid and enzymes if they have nothing to digest at the moment?
After the increase in muscle mass, the growth of intestinal villi is where the post-weaning piglet dedicates more energy and nutrients to improve the absorption of any available nutrients..
If the piglet does not eat and does not produce digestive enzymes, why does it need to improve the absorption of nonexistent nutrients? Hence, the development of the mucosa of the small intestine is reduced.
However, after 20-24 hours without eating, the hungry piglet overeats, bringing more feed than necessary to a digestive system that is not prepared, with limited production of hydrochloric acid and enzymes, and intestinal villi in the process of deterioration.
In this situation, part of the ingested feed passes undigested to the large intestine, where we will have problems with the excessive proliferation of pathogenic microbiota, such as clostridia and coliforms.
What are the key points regarding postweaning feeding?
It is important to ensure high consumption by the piglet prior to weaning, consumption that should be maintained during the postweaning period, as long as the piglet remains healthy and without diarrhea.
In the presence of digestive processes, the production objective changes:
we do not want the piglet to grow more, but rather to control diarrheal processes. If the piglet recovers from diarrhea, it will regain its weight in a short time, and the productivity at slaughter will not be compromised.
In the presence of diarrheal processes, when the animal’s health takes precedence over growth, it may be more convenient to provide a feed in meal form that is not excessively fine rather than a pelleted feed.

Likewise, it may make sense to reduce the protein content and increase the content of inert fiber in the feed, despite their possible negative effect on consumption and growth.
An important aspect to consider is to avoid excess nutrients in the large intestine in order to reduce the incidence of abnormal fermentations.
In this regard, it is worth establishing a clear difference between the two key components of feed: carbohydrates and proteins.
In general, it is estimated that more fermentations in the cecum lead to more digestive problems, which is not necessarily true.
The fermentation of carbohydrates is probably less harmful (not necessarily beneficial) than we have always believed.
The fermentation of proteins, with the consequent production of ammonia, indoles, and other nitrogenous waste products, is probably more problematic than expected.
The fermentation of hydrocarbon chains results in short-chain volatile fatty acids that are absorbed and used as a direct energy source by the piglet.
On the other hand, fermentation of the nitrogenous fraction leads to alkalinization of the tissues and disproportionate growth of Clostridium sp. and other pathogenic microorganisms in the large intestine.
In case of enteric problems, we should be much more concerned about an excess of protein than an excess of carbohydrates.
In any case, the main objective should always be to maintain an adequate health level of the piglet’s gastrointestinal tract in the post-weaning period.
What are the feeding objectives of piglets weighing 7 to 10 kg?
Before the prohibition of the use of pharmacological doses of zinc oxide, the objective was clear: to achieve good daily weight gains and exceptional feed conversion rates at minimum cost.
In order to achieve this goal, early weaning (<22 days of age) predominated with mortality rates and delayed piglets of less than 4-5% during the pre-fattening period, thanks to the preventive use of antibiotics and therapeutic doses of zinc oxide (ZnO).
Today, in the absence of this safety net incidence of diarrhea and mortality during the first 10 to 15 days post-weaning has notably increased. As a consequence, mortality and the percentage of delayed piglets initially increase.
For this reason, later weanings are sought to obtain piglets that are physiologically more mature and can more easily overcome the post-weaning stress.
Based on these changes and our own learning, the problem can and should be overcome, as we are seeing in countries in our economic environment, such as the Netherlands.
In summary, we need to learn how to manage piglets without zinc oxide and without antibiotics, and for this, we already have examples and practical technologies to follow.
The ultimate goal of the process is clear, and I can confirm that it can be done: to achieve pigs with live weights and slaughter conversion rates similar with or without zinc oxide.
But the necessary changes to produce healthy piglets in the absence of ZnO require time and dedication, and above all, following a logical course of action.
The performance losses, mainly due to low weights and high conversion rates, that we will have during the early post-weaning phases without using zinc oxide can be recovered during the fattening phase, with pigs that will respond much better to any medication, if necessary.
This makes sense, as at the end of its productive cycle, a healthy pig gains over 1 kg/day, while in the post-weaning period, daily growth barely reaches 300350 g/day. Therefore, a healthy animal recovers in a few days any potential losses it could have had from not using zinc oxide (always in the absence of diarrhea).


Minimize stressful situations to the minimum, not suffer from anything and is seen attentive and happy. Just like with humans, a stressed piglet is not thinking about eating.
Only wean mature piglets
28 days of age and an average live weight of around 7 kg. Without the use of ZnO, we need mature piglets.
Ensure good litter uniformity. have 16 piglets/litter, as is common today, we are not going to have uniform weights, so we must wean them at an older age and improve animal handling and care.
Pay attention to feed grinding. grinding improves feed digestibility but harms the piglet’s digestive physiology to some extent. We have to choose!

Control the presentation and quality of ingredients and feeds, as well as the manufacturing processes.
Avoid long storage in the factory of expensive, high-value-added ingredients.




into fat, via the Krebs cycle, but the nitrogen
An additional problem is that exogenous phytases, commonly used in pig feeding, are not able to degrade phytates, an important antinutritional factor, if they are not solubilized..
In case of high pH in the proximal digestive tract, as occurs in the post-weaning period, the activity of phytases and, therefore, the availability of phosphorus may be compromised.
Therefore, it is important to keep the levels of Ca and crude protein in postweaning feeds under control.
Traditionally, fiber has been considered a diluent and an antinutritional factor in earlyage feeds.
The generally accepted philosophy was that the less fiber, the better, as excess fiber reduced consumption and affected the digestibility and growth of the animals.
It was believed that an excess of fiber favored the colonization of the gastrointestinal tract by pathogenic microorganisms and, therefore, increased the incidence of postweaning diarrhea.
However, this belief is not necessarily correct and depends largely on the hygiene, health, and age of the animal, as well as the source and level of fiber in the feed.
When we talk about piglets with digestive problems, we are mainly referring to the benefit of supplying insoluble fiber.
Insoluble fiber is poorly fermentable and, therefore, does not produce volatile fatty acids that can be absorbed into the digestive mucosa and serve as energy for damaged colonocytes.
However, this insoluble fiber affects intestinal motility, increasing the speed of digesta transit in the small intestine and reducing the capacity of bacterial adherence to the digestive mucosa.
The growth of the microbial flora requires:
1. A high digestive content as a substrate.
2. A limited transit speed to have time to ferment the digesta, grow, and multiply.
With the use of insoluble fiber, motility and movement of undigested digesta are increased, reducing the opportunity for bacteria to grow and develop. All this results in changes in the microbiota profile, with possible effects on its diversity.




Another important issue, which is often overlooked, is the macromineral fraction of feeds calcium, on the digestive physiology and growth of the piglet.
Calcium is necessary for harmonious growth of bone tissue. However, it affects the palatability of the feed and interacts with phosphorus absorption, increases pH due to its buffering capacity, reduces the activity of pepsin and phytases, causes dysbiosis in the gastrointestinal tract, and occupies space in the formula.
Additionally, the negative effect of an excess of calcium on the integrity of the digestive mucosa has recently been studied, with an increase in the incidence of processes caused by Clostridium perfringens
Calcium is probably the most expensive nutrient, despite its low price, in piglet feed.
To conclude, regarding antibiotics and additives:
There are no additives that can replace zinc oxide, but there are some that can help the piglet defend itself against stress and problematic environmental situations.
While it is true that antibiotics reduce the growth of pathogens and, therefore, control digestive problems, their use also reduces the diversity of the intestinal microbiota, causing an imbalance and an increase in pathogen resistance.
Additives have a lesser effect on the growth of pathogens than antibiotics, but they promote the diversity of the intestinal microbiota and allow for a greater subsequent response, when necessary, to curative antibiotic treatments.




BACKGROUND
S. Jalukar1, C. Rippe, and S. Fribourg2
1 Arm & Hammer Animal Nutrition, Princeton, NJ
2 Adisens, Peru
OBJECTIVES
Benefits of CELMANAX supplementation in sow and nursery pig diets on sow and nursery pig performance have been seen before1,2. However, long term benefits on finishing pigs have been assumed based on heavier weaning weights, but not previously documented.
The first objective was to determine the benefit of CELMANAX supplementation one month before farrowing and through lactation on sow performance.
The second objective was to measure benefit of continued CELMANAX supplementation in the nursery on finishing pig performance. 1 2
TRIAL METHODS
The study was conducted in a commercial research barn in Peru.
Sows (PIC) (18-27 per pen) group housed in 6 pens, were allotted to two treatments, three pens (replicates) per treatment.
Weaned pigs were transferred to multiple nursery pens, 35 pigs in each pen.
One week prior to expected farrowing date, sows were moved to individual farrowing crates.
The Sows were fed gestation and lactation diets without CELMANAX (control) or with CELMANAX SCP 200 g/MT one month before their farrowing date and in lactation.
Weaned pigs from control fed sows received control diet in nursery and those from CELMANAX fed sows received CELMANAX SCP, 200 g/MT during nursery.
Phases 1 and 2 - Doxycycline (1.2 Kg/MT) approximately 10 – 20 mg / kg of body weight (BW) and in Phases 3 and 4 - Florfenicol (1.5 Kg/MT) approximately 2.5– 10 mg / kg BW.
DATA COLLECTION
No CELMANAX was supplemented during grow-finish phase.
Piglets were provided creep feed and were weaned at 21 days of age.
Conventional nursery diets based on corn and soybean meal, with milk substitute and plasma (5% Phase 1, 4% Phase 2 and 2.5% Phase 3) containing pharmacological levels of Zinc Oxide and antibiotics were fed.
For sows, wean to estrus interval (WEI) and % pregnancy rate was measured. Piglet BW at birth, at weaning, and at end of nursery and % preweaning survival were measured. Carcass weight and feed efficiency (FE) were measured when the pigs were marketed.
DATA ANALYSIS No statistical analysis was performed.
CELMANAX supplementation reduced WEI for sows (Figure 1)
The performance data for the sows, nursery and grow-finish pigs is presented in Table 1
Piglets from CELMANAX supplemented sows were heavier at birth and weaning.
CELMANAX supplementation in nursery diets improved weight gain in nursery and reduced feed/gain (Table 1)
As a result, pigs from the CELMANAX group were 2.4 kg heavier compared to control pigs at the end of nursery phase.
Even though CELMANAX was not supplemented in the grow-finish phase, pigs that received CELMANAX during nursery had 5.4 kg heavier carcass weights and a reduced feed/gain by the end of grow-finish period compared to control pigs (Table 1)
Table 2. Net profit
Fixed costs used in calculation
Market price of pork, 5.8 Soles/kg, Cost per day to breed a sow, 10.95 Soles
Cumulative grow-finish feed cost per pig, 219.00 Soles
A direct correlation between BW at weaning and end of nursery phase on growth rate and feed efficiency in grow-finish pigs has been reported before3. This study shows that CELMANAX supplementation in sow and nursery pig diets resulted in additional profits of 28.33 Soles per pig at slaughter (Table 2).
References
CELMANAX supplementation in sow and nursery pig diets can improve performance and profitability for a swine producer.

Carolina Kyriacou
Nutritional Consultant from Vettaky LTD, Cyprus
MSc from the University of Wageningen, Netherlands
We all know how crucial the early stage in a dairy calf’s life is for its future success as a dairy cow. In Cyprus, where I live, I experience on an annual basis, just how important that care is, when calves are born in the hottest month of the year in a hot climate.
Mastering that challenge is what you might call “calf rearing for the advanced”. I would like to share some calf nutrition and management practices that play a key role on dairy farms in Cyprus and other hot environments.



August is the hottest month in Cyprus with temperatures averaging around 32°C. Adding the humidity coming from the sea, cows and people are continuously at risk to suffer from heat stress, much more than in other European countries.
Still, it is common practice for dairy herds in Cyprus to manage the calving cycle of their cows for a batched calving season in late August. The main reason being that is it is difficult to get cows into calf during the hot summer months.

You could say it is a highly uncomfortable environment for a calf to be born into. Plus, with the mothers most likely experiencing some level of heat stress in the late stages of pregnancy, calves will already be disadvantaged in their start, before they were even born.

Heat stress reduces the duration and intensity of estrus, resulting in silent heat or weak estrus expression, making it difficult to detect cows on heat.

On top of that it can depress follicular development leading to poor quality oocytes in cows, which altogether reduces the probability of successful inseminations.
As a result, conception rates in dairy cows are generally low between July and September in Cyprus. Additionally, carry-over effects from the summer months can result in cystic ovaries in October, such that most dairy cows are generally not inseminated until November.
Several studies found calves born in the summer had significantly lower average daily gains than calves born at other times of the year, independent of housing types.
Increasingly high summer temperatures and high humidity can cause heat stress in calves.
This leads to reduced feed intake and increased maintenance energy needs coupled with lowered immunity, which are all factors contributing to poor growth and higher susceptibility to disease.

The other disadvantage dairy calves in Cyprus are very likely to experience, occurs before they are even born. Their mothers are at high risk to experience heat stress in late pregnancy.
Research has shown decreased birth weights in calves born to dairy cows experiencing heat stress in the last 8 weeks of pregnancy.
Furthermore, studies found that heat stress in the dam did not only compromise foetal growth but also immune function of offspring from birth to weaning. Additional negative impacts of dams experiencing high temperatures during late pregnancy are drops in the quality and quantity of colostrum.
Others have reported that the negative prenatal heat stress effects could persist in the future stage of calves. Calves that experienced maternal heat stress produced less milk in the first lactation than calves with mothers that were kept in a cool environment.



The positive relationship between preweaning daily gain in dairy calves and their future lifetime productivity as dairy cows is scientifically proven. Hence why the impact of early life nutrition in calves and its opportunity to improve long-term cow health, performance and welfare is a hot topic.
Dairy calves born in Cyprus are really dealt a tough hand at the beginning of their life. This requires farmers to pay extra attention to detail when caring for their calves, if they want to see them grow into high producing resilient dairy cows.
Mitigating heat stress in calves will support their growth and development and lays the foundation for a productive and healthy dairy herd.
Calves can double the amount of water intake to help them handle heat stress and stay hydrated.
Research from the Iowa State University in the US has shown that the importance of offering water from the start of a calf’s life has been underestimated. While on farms it was much more common practice to offer free-choice water after calves were 17 days of age, this research suggests that providing supplemental drinking water starting at birth can benefit growth performance in calves.
Furthermore, the researchers observed improved nutrient digestibility and improved rumen function leading to increased feed efficiency in calves being offered water starting on day 1 of life. It is good practice to introduce each calf to water to ensure they understand water is available.


On top of that adding electrolytes to the drinking water has been shown to be beneficial particularly during times where calves are at risk of heat stress. Electrolytes can help restore imbalances associated with heat stress and dehydration and prevent calf scours.
In high temperatures calves will burn more energy as they try to lower their body temperature, which leaves less energy available for growth.
Coupled with a decrease in feed intake in response to environmental heat, calves will grow much slower during the heat.
However, studies have shown that heat stress is more likely to affect starter intake than milk replacer intake. Increased feeding rate of milk replacer (0.66 kg vs. 0.44 kg dry matter/d, 21% crude protein, 21% fat) increased average daily gain and hip width in calves raised in summer months, confirming that increased feeding rates of milk replacer can help to overcome some of the average daily weight gain lost during heat stress in young dairy calves.
Canadian researchers led by Steele promote feeding higher levels of milk in the first 4 weeks of life to optimize growth pre-weaning, regardless of environmental temperature.
This article only focuses on some of the management practices that can affect the impact of nutrition in calves and are of increased importance in a hot environment.
Since the quality of colostrum is of magnified importance in calves born into a hot environment, storage and handling of colostrum requires extra care to maximize quality.
Best practice is to store the colostrum in flat bags and not in plastic bottles in the freezer. It also pays more to monitor the quality of the colostrum continuously very closely for IgG levels to ensure calves are receiving adequate passive transfer.
As explained above colostrum quality often declines during the summer months. On top of that there is greater risk for bacteria and disease organisms to multiply, so colostrum should also be sampled routinely for coliforms to reduce the risk of feeding dirty or contaminated colostrum to calves.


The drinking water hygiene plays a crucial role for the health of the calf at the best of times.
However, hygiene management for the buckets and water provided needs to be extra strict in a hot environment, where pathogens will multiply more quickly. Empty and refill water buckets at least twice a day to keep water fresh.

One more thing to have a very close eye on, is making sure to keep the calf starter and grain fresh.
During the hot months, flies, mould and heat spoilage are a greater problem.
On the other hand, calves also eat less when they are hot. So, it is a challenge to ensure that the grain supply is fresh at all times and needs to be checked more frequently and discard uneaten portions.
Offering smaller amounts of fresh calf starter more often will decrease spoilage and help intakes. Supplementing the calf starter with a fly control additive can help to reduce the fly population and spread of disease.


What you feed a calf in the first 60 days of its life can determine its performance as an adult cow and it is not just the quantity that is important, it is also the quality.
A proactive approach to establishing a healthy gut in calves can minimize financial losses in the form of calf treatments and morbidities, but also secure better growth rates and feed efficiency.
The gut serves as the main organ for nutrient absorption and acts as the first line of defense until the immune system cells have fully developed in the calf. A healthy gut is dependent on a well-balanced microflora.
However, the microbiota of newborn calves is highly sensitive to changes in diet, environment, disease, and stress. A hot environment will exacerbate the impact of these factors on the development of the gut micro-flora, exposing the calf to a greater risk for reduced nutrient absorption and health challenges.
Fortifying the calf diet with selected proven feed additives, known for their positive effects on the gut microflora in calves can result in healthier, more resilient calves and make your nutritional efforts go further.
Another important capability to consider in calves, particularly in a hot environment is their antioxidative capacity to minimize oxidative stress.
Oxidative stress results from the imbalance between the production of free radicals and the availability of antioxidant defenses that are needed to reduce free radical-induced cellular oxidative damage or dysfunction.
Exposure to heat stress has been shown to increase the production of free radicals in the body. Oxidative stress has become a topic of interest in the neonatal period because it negatively affects lymphocyte function, which might affect vaccine response.

The positive impact of nutritional strategies supporting the antioxidative capacity through antioxidant supplementation on reducing oxidative stress is widely studied in mature cows. In mature dairy cattle, substantial evidence shows the beneficial effects of antioxidant supplementation on redox balance, health, and production outcomes.
The topic is still less well studied in calves, however there is some evidence that antioxidant supplementation can benefit the antioxidant status of calves.
For example, a recent study showed that zinc supplementation of 80 mg/day in the form of zinc proteinate during the first 2 weeks of life reduced the incidence of diarrhea, increased the growth performance and improved the antioxidant and immune functions in dairy calves during the first 4 weeks of life.
Other studies have shown that the supplementation of vitamin E and vitamin C have a beneficial effect on growth and antioxidant capacity of neonate calves.
References upon request


Fernando Ignacio Castillo Ortega
Veterinarian Zootechnician from the Autonomous Agrarian University Antonio Narro (UAAAN)Laguna Unit, Saltillo, Coahuila, Mexico
In recent years, livestock farming has undergone significant technological and productive changes. In the face of global economic processes, the only way forward is to be competitive. In our conditions here in La Laguna, Torreon, Mexico, intensifying production involves significant specific changes in animal welfare. This is a key aspect that does not correspond to just one aspect or particularity but to an entire team working in a dairy farm.





The presence of lame cows would not be considered of major importance if the incidence were only occasional. The animal would be treated with more or less success, and that would be the end of it.
However, the number of lame cows has marked a considerable percentage in some cases, qualifying it as one of the most prevalent and costly conditions.
Lameness in dairy cattle is one of the most common reasons why a large number of cows are prematurely sent to slaughter. Adding to this loss is reduced production, withdrawal of milk due to medication use in affected cows, and the cost of treatment, there is a direct economic impact.

With similar importance to mentioned above, and qualifying it as an indirect loss, poor reproductive development can be seen, as the conception rate in affected animals decreases, there is low dry matter intake, marked loss of body condition, and a possible relationship with the onset of another secondary disease such as mastitis.
Therefore, economic losses occur as a result of the consequence rather than the “disease” itself.
The etiology of lameness is multifactorial, and although we generally divide lameness by: metabolic, mechanical, and infectious origins,
it means that there are various factors and combinations of them that, when reaching a critical point, trigger the disease.
Therefore, the evaluation of the lesions present in the affected hoof, with a correct diagnosis, will mark two paths to follow:
the first is the adequate treatment for a quick recovery, and the other, perhaps more important, is the data collection that can indicate where we should start to prevent, which is much cheaper.
Here lies the importance of having stable staff trained to carry out this work.

Nutrition is one of the most important factors that can play a determining role in lameness problems in dairy cows.
There is much discussion about the relationship between nutrition and lameness concerning the level of functional or effective fiber, the amount of fiber, the amount of grain, degrees of grain fermentation, the forage-to-grain ratio in the dairy cow’s ration, and subsequent acidosis.
The amount of research examining the effect of nutrition on the hoof is limited. This can be partially attributed to both the time commitment required to see the effect of a change in nutritional programs on lameness incidents and the lack of adequate knowledge of the hoof by researchers.
However, it is very evident that certain feeding regimes, diets, metabolic disturbances, and infectious diseases result in significant and prolonged drops in rumen pH, leading to a dramatic increase in lameness.
Dr. Nocek summarized these damages in a diagram with the cascade of events that frequently lead to ruminal and metabolic conditions resulting in dairy cow lameness.
The key factors in this cascade are feed management, molds/mycotoxins (feed/ forage quality), infectious diseases, and the management of metabolic disorders, environmental impact, and genetics.
Many of these variables lead to ruminal disturbances resulting in the death of gram-negative bacteria and the production of endotoxins, leading to a vasoconstriction/dilation response within the hoof.
This disturbance in blood and nutrient flow results in the production of poorquality horn tissue and, if severe enough, the death of laminar horn tissue and acute lameness.
Nutrition
Excess grain
Finely chopped forage
Inadequate feed management,
Incorrect forage-to-concentrate ratio
Metabolic Disorders
Milk fever
Ketosis
Weak hooves
Rupture of supportive connective tissue
Formation of poor-quality horn tissue
LAMENESS
Infectious Diseases
Metritis
Mastitis
Retained placenta
Management/Environment
Stress
Trauma
Exercise
Trimming
Image 1: Ruminal disturbances resulting in the death of gram-negative bacteria and the production of endotoxins, leading to a vaso-constriction/dilation response within the hoof causing lameness
Respiratory Alkalosis (CO2)
Urinary Bicarbonate, Loss of Saliva from Drooling, Rumen pH

Vasoconstriction/Dilation
Weak Hooves
Rupture of Supportive Connective Tissue
Formation of Poor-Quality Horn Tissue
LAMENESS

Humid Environment
Cooling system for cows
Accumulation of manure
Muddy areas
Hooves soften, resulting in excessive wear
Image 2: Potential impact of heat stress on hoof integrity and lameness
Vitamins play important roles in maintaining hoof integrity. Generally, cows in Mexico are supplemented with vitamins A and E to ensure an adequate supply of carotenoids and tocopherol, both of which are important in maintaining skin integrity and immunity.
Additionally, vitamin D is supplemented to maintain calcium metabolism.
In the past, B vitamins were generally not administered to mature ruminants. However, recent research indicates that rumen microbes involved in biotin synthesis are sensitive to low pH.
Therefore, cattle fed high-grain diets or high-quality pastures may develop subclinical biotin deficiencies. Biotin is a water-soluble vitamin essential for the formation and integrity of
Its role in the formation and integrity of keratinized tissues is related to its role in the differentiation and keratinization of epidermal tissues that produce hoof horn and skin.
Biotin reserves drop dramatically during periods of stress and lameness, resulting in reduced keratinization and production of the intercellular cement substance of the hoof horn. The horn tissue produced during a biotin deficiency would be soft and weak.
Results indicate that the biotin status of cattle appears to be marginal, as evidenced by the improvement in hoof integrity in response to supplementary biotin. Administering 10 to 20 mg/head/ day of supplementary biotin will result in a reduction of hoof disorders such as

An area of nutrition that is commonly overlooked is the role of trace minerals in improving hoof health, structural integrity, and reducing the incidence of lameness.
Iodine is required for the synthesis of the thyroid hormone thyroxine, which regulates the degree of metabolism. Signs of subclinical iodine deficiency include increased occurrences of hoof disease and respiratory illnesses.
Several studies have shown the benefits of administering iodine in the form of ethylenediamine dihydroiodide (EDDI) above the nutritional requirement to prevent hoof disease. When cattle were intradermally inoculated in the interdigital space with a mix of Fusobacterium necrophorum and Bacteroides melaninogenicus to induce acute hoof disease, cattle receiving 12.5-200 mg/animal/day of EDDI had less lameness compared to control cattle.
The recommended iodine content in the diet for lactating dairy cattle ranges from 0.3 to 0.9 ppm, depending on the stage of the lifecycle and dry matter intake (NRC, 2001).
Soybean and canola increase the animal’s iodine requirement as they contain goitrogenic compounds that reduce iodine availability. Additionally, high levels of nitrate in the diet inhibit iodine uptake by the animal.
Therefore, producers with nitrate-rich forage and/or water need to assess whether iodine supplementation levels are adequate.
Before 1957, the nutritional significance of selenium was related to its toxicity. Nowadays, selenium is recognized as an essential element that defends the body against oxidative stress.

The selenium-containing enzyme glutathione peroxidase prevents the formation of free radicals that cause cellular damage
Symptoms of selenium deficiency include immune suppression, reduced fertility, and weak or silent heats.
Symptoms of chronic selenium toxicity include lameness, inflamed and deformed hooves, and loss of tail hair.
In pregnant animals, selenium toxicity can lead to abortions, stillbirths, and weak, lethargic calves because selenium accumulates in the fetus at the expense of the cow.

Placental retention, metritis, and mastitis have been reported to predispose cattle to hoof problems. Administering vitamin E and selenium has long been associated with reducing the incidence of retained placentas and uterine infections. However, dairy producers need to be aware that oversupplementation of selenium can increase the incidence of lameness. The selenium requirement is 0.33 ppm. Calcium, copper, zinc, and sulfur reduce selenium absorption.
Zinc is an essential component of various enzyme systems. Metabolic actions of these systems include carbohydrate and energy metabolism, protein synthesis, nucleic acid metabolism, epithelial tissue integrity, cell repair and division, and transport and utilization of vitamin A.
Additionally, zinc plays a crucial role in the immune system and certain reproductive hormones.
It is theorized that zinc enhances hoof integrity by accelerating wound healing, increasing epithelial tissue repair rate, and maintaining cellular integrity. Zinc is also required for the synthesis and maturation of keratin.

In dairy barns with a high incidence of hoof problems, cows fed 2 to 3 g/day of zinc sulfate for 70 days experienced fewer hoof issues compared to cows not receiving zinc supplementation.
The lack of consistent response to inorganic zinc feeding can be attributed to antagonists present in the diet reducing the bioavailability of inorganic zinc.

Zinc sources in the form of complexes, such as zinc methionine, have proven to be more bioavailable than zinc from inorganic sources, as they are less affected by diet-related antagonists.

Several studies have shown that zinc complexes improve hoof integrity. Cows receiving zinc complexes had fewer cases of heel fissures, ulcers, white line lesions, and interdigital dermatitis compared to cows not receiving zinc complexes. Additionally, the incidence of plantar ulcers and white line disease tended to decrease.
Another event that occurs during the prepartum period, which can affect hoof integrity, is the maternal transfer of copper to the developing fetus. Copper status is lower in late gestation and early lactation, making cows more prone to copper deficiency during this period.
The question is: do reduced maternal copper reserves result in the formation of less tightly bound connective tissue, resulting in greater tissue elasticity?
The required copper content in the diet for dairy cattle is 10 ppm, depending on the stage of the lifecycle and milk production level. It should be noted that copper requirements assume normal levels of stress and antagonists.
Copper availability is greatly reduced by sulfur and molybdenum, as they form insoluble complexes that provide unavailable copper to the animal.

Zinc and iron also reduce copper availability for the animal.

The requirements for zinc and copper illustrate the importance of trace mineral supplementation in late gestation and early lactation.
Moreover, if zinc and copper requirements, along with other trace minerals, are not met, dairy cattle would be predisposed to increased lameness in early lactation.

Graphic: Effect of the relative day to parturition on the copper status of dairy cattle as measured by liver copper concentration.
Manganese plays a role in various enzyme systems and is required for cartilage and collagen formation, as well as bone growth.
Additionally, it plays an important role in reproduction.
Animals suffering from clinical manganese deficiencies will exhibit skeletal abnormalities, twisted legs, and shortened tendons as noted on the legs.
Manganese helps minimize hoof problems by maintaining proper hoof formation.

The primary physiological role of cobalt is as a component of vitamin B12 (cyanocobalamin). Vitamin B12 sources in the diet are not efficiently used by ruminants due to inactivation by ruminal microbes.
The required manganese content

Chromium enhances insulin action, resulting in increased glucose and amino acid uptake by cells in the body. Signs of chromium deficiency include reduced growth rate, reduced feed efficiency, and reduced immune function.
Trace minerals, in addition to zinc, play important roles in maintaining hoof integrity.
Therefore, it is not surprising that administering a combination of zinc,

tended to reduce the incidence of dorsal wall cracks (10.4 vs. 11.7%).


Feed management is as important as the ration itself; improper diet management will greatly contribute to having hooves lacking the necessary resistance.
In addition to ensuring that cows consume diets with adequate amounts of effective fiber and acceptable amounts of NFC, dairy producers need to implement management practices that minimize “junk” feeding, especially in early lactation.
Risk Factors in Hoof Health in Dairy Cows DOWNLOAD ON PDF
Locomotion scoring can serve as an early warning system for potential hoof disorders. Animals should be scored and identified as candidates for corrective trimming on a routine basis, such as at calving, reproduction, drying off, selection, and daily milking.

Early identification, corrective trimming, attention to cow comfort, non-slip flooring, and ensuring adequate nutrition, including trace mineral complexes, can improve overall hoof health and positively impact performance and profitability.
Meeting the true requirements that dairy cows need involves not only understanding the animal’s requirements but also the factors that will affect the amount of trace minerals needed in the diet to meet those requirements.
Administering research-proven organic trace minerals is a good way to minimize the risk of animals developing trace mineral deficiencies that compromise hoof integrity and can lead to lameness.
Prompt identification of any movement abnormality in each animal gives us a greater opportunity for correction regardless of the origin of the hoof problem.




Evolving from an international feed additives blending company into a global group and primary producer.
We offer full-service solutions. From natural feed supplements to advanced bio-monitoring tools.



